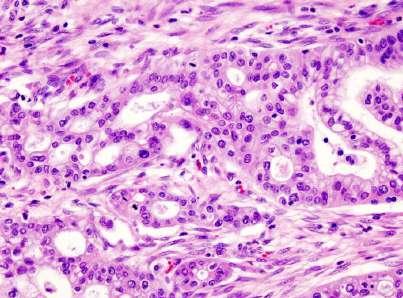

E FARMACEUTICA


























![]()






























5500 Texlon® self-adhesive soft tapes
A self-modelling gasket tape made of soft and flexible non-sintered expanded 100% PTFE. Texlon® resists chemical products with the exception of alkaline substances and is usually supplied with bi-adhesive film which facilitates application. The PTFE raw material is WRAS Approved.
3356 SUREBAND CLEAR Shields
Manufactured from All-PTFE materials (no fibreglass) comprising clear ETFE outer and multi-layered ETFE mesh inner. This material provides unparalleled chemical resistance. All our shields are tested on our hydro-static pressure test facility, test certificates available on request. The internal mesh is compressed against the flange and prevents direct and lateral spray. The liquid pressure inside is rapidly diffused, resulting in a safe drip-release.
5100L PTFE Sheets
PTFE plate, polymer belonging to the class of perfluorocarbons (PFC), resulting from homopolymerization of tetrafluoroethylene. The same plates can be made with the addition of other stabilizing and thinning components, to expand their application range. Alternatively, they are available with added glass, silica, carbon, bronze or barium sulphate charges to increase their mechanical, pneumatic and chemical resistance. The main features of PTFE are the excellent thermal, chemical resistance and the low coefficient of friction.
When producing joint gaskets, some fundamental criteria must be borne in mind without which it would be impossible to obtain a perfect seal between two flanges. In particular, the gasket must comply with the following requirements: adaptability to the surfaces of the flanges and any irregularities; impermeability to contact agents; resistance to the specific pressure applied by the flange tightening bolts. Furthermore, it is very important to avoid the release of substances that could contaminate the product.





Reshaping technical support with lifecycle catalyst solutions









“The Action Plan for the Chemical Industry includes all levers to put the sector back on a growth track, from production-support measures to keep our steam-crackers and chemical sites in Europe, to trade defence instruments to protect our chemical businesses from unfair global competition, all the way to securing domestic demand for clean & ‘made in Europe’ chemicals.” Stéphane Séjourné, Eu Commission Executive Vice-President for Prosperity and Industrial Strategy, page 13.








by Alessandro Bignami
Pharmaceutical research is undergoing a period of great dynamism, with an increasingly evident impact on patients’ quality of life and life expectancy – thanks, for example, to the rapid development of gene and cell therapies. Certainly, many challenges remain, starting with the treatment of Alzheimer’s disease, multiple sclerosis, certain cancers, and various rare diseases. However, scientific and technological progress – further accelerated by artificial intelligence – is fueling hopes of achieving, in the not-sodistant future, improvements even in the treatment of diseases that are currently extremely difficult to manage. The progress made in research over recent decades has been driven by major investments from the pharmaceutical industry, which has long been a key high-tech sector in developed countries. Europe has played a leading role in this evolution, establishing itself as a beacon in the field of pharmaceutical research and the production of highly innovative drugs. Today, the European pharmaceutical sector directly employs 950,000 people – a figure that triples when including the broader supply chain – and invested €55 billion in research and development in 2024, according to PwC data. In recent years, however, the landscape has changed, and Europe has lost ground in the pharmaceutical sector compared to major economic and technological powers such as China and the United
States. It has also been challenged by emerging markets like India and Brazil, where many production and R&D activities are relocating. In 2024, the largest market was North America, accounting for 54.8% of global pharmaceutical sales, compared to Europe’s 22.7%. Only 15.8% of new drugs were launched in Europe, far behind the United States at 66.9%, according to Iqvia Midas data. Last year, Europe ranked third in the number of new molecule launches, with 18 – behind China (28) and the United States (25).
For this reason, European stakeholders had hoped for a favorable and specific agreement on tariffs for pharmaceutical trade between the EU and the U.S. Instead, medicines were included in the 15% tariff rate, with exemptions granted only to certain generic and off-patent drugs – although it remains unclear which ones. Ongoing uncertainty, aggressive global competition, and the complexity of European regulations have all contributed to this decline – one that risks being exacerbated by Trump’s tariffs. Now, the continent must reclaim its position at the top of the global industry, leveraging its vast potential in terms of expertise, technology, and research infrastructure. To achieve this, not only is industry commitment required, but also a stronger and more unified political voice that can fully support the value of European pharma.







PVS has launched a collaboration with ITS Nuove Tecnologie della Vita Academy to support the development of students’ skills in the pharmaceutical plant sector.


In a constantly evolving sector like pharmaceuticals, training is a fundamental pillar in preparing tomorrow’s professionals.
With this in mind, PVS – a company that provides consultancy, validation, qualification, and on-site calibration services for the pharmaceutical industry –has partnered with ITS Nuove Tecnologie della Vita Academy, a post-diploma technical school. The Academy offers various two-year courses, including programs focused on the chemical-pharmaceutical sector.
Specifically, PVS is involved in the following activities:
Technical teaching - PVS is currently delivering the second part of the Chemical Plants module in the Pharmaceutical Plants course, contributing concretely to
skill development in the sector by bringing direct experience into the classroom and offering students a hands-on, operational perspective.
PCTO training module for high schools - PVS has launched a module on Safety in Drug Manufacturing, aimed at raising awareness among younger students about critical topics in the pharma world. The module provides a structured introduction to GMP, regulatory frameworks, and technologies used in pharmaceutical production.
Company presentation and career orientation - Through dedicated meetings with ITS students, the company shares insights on what it means to work in consulting, the skills required, and the professional opportunities available. For PVS, this collaboration is a strategic investment. The company believes that education is a driver of growth and innovation and wants to actively contribute to shaping a new generation of skilled and aware specialists.
That’s why PVS sees knowledge transfer as essential to creating shared value –both for the education system and the industrial landscape
Experts in validation and qualification activities
PVS was founded in 2013 by bringing together diverse experiences and expertise. It is a flexible and dynamic organization, capable of adapting to the needs of different stakeholders and players in the target market. Thanks to strong relationships and positive interactions with major national and international pharmaceutical groups, the company has steadily expanded its team with new professionals.
Its activities range from consultancy to GxP-compliant validation and qualification services. With the addition of skilled professionals, the company also provides consultancy, support, and validation services for Total Organic Carbon (TOC) analyzers used to measure this parameter in water for pharmaceutical and electronic use, as well as for special applications.
Concrete answers to employment needs in the sector
ITS Nuove Tecnologie della Vita - G. Natta Academy is a post-secondary technical specialization school and the only Higher Technological Institute in the chemical field in Italy.
Its training offering belongs to the tertiary level of education, running parallel to academic programs. It is closely connected to the production system and labor market, making it capable of responding to the need to train highly specialized technical-scientific professionals to support the competitiveness of companies, especially those seeking young talent able to navigate the evolving landscape of technological innovation.
The institute is committed to providing concrete responses to the real employment needs of the region by offering highly specialized training programs. The Academy focuses on the internationalization of the ITS system and actively involves companies in the design and planning of its educational pathways.
AstraZeneca announces $50 billion of investment in the United States by 2030, building on America’s global leadership in medicines manufacturing and R&D. This investment is expected to create tens of thousands of new, highly skilled direct and indirect jobs across the country powering growth and delivering next generation medicines for patients in America and worldwide.
The cornerstone of this landmark investment is a new multi-billion dollar US manufacturing facility that will produce drug substances for the Company’s innovative weight management and metabolic portfolio, including oral GLP-1, bax-
drostat, oral PCSK9 and combination small molecule products. The new state-of-the-art centre will produce small molecules, peptides and oligonucleotides. This multi-billion dollar capital investment is in addition to the $3.5 billion announced in November 2024.
The drug substance facility, planned to be in the Commonwealth of Virginia, would be AstraZeneca’s largest single manufacturing investment in the world. The facility will leverage AI, automation, and data analytics to optimise production. The $50 billion investment across our R&D and manufacturing footprint in the US over the next five years also includes: ex-
pansion of our R&D facility in Gaithersburg, Maryland; stateof-the-art R&D centre in Kendall Square, Cambridge, Massachusetts; next-generation manufacturing facilities for cell therapy in Rockville, Maryland and Tarzana, California; continuous manufacturing expansion in Mount Vernon, Indiana; specialty manufacturing expansion in Coppell, Texas; new sites to supply clinical trials; our growing research and development investment in novel medicines.
Collectively, these investments will help deliver AstraZeneca’s ambition of reaching $80 billion in Total Revenue by 2030, of which it is expected 50% would be generated in the US.

The US is AstraZeneca’s largest market and home to 19 R&D, manufacturing and commercial sites. The company employs more than 18,000 people and support 92,000 jobs overall across the United States. In 2024 it contributed $5 billion directly to the economy and created approximately $20 billion worth of overall value for the American economy.

Air Liquide will invest up to 200 million U.S. dollars in Louisiana, U.S., to modernize and connect an Air Separation Unit (ASU) to its existing network. This investment also includes the expansion of its pipeline infrastructure by an additional 30 miles along the Gulf Coast. These enhancements supporting a long-term contract renewal with Dow will strengthen the Group’s long-term relationship with them. Additionally, this reinforced network will position Air Liquide to support industrial growth in Louisiana. In the context of a long-term renewal contract, Air Liquide will continue to supply
oxygen and nitrogen to Dow’s St. Charles Operations site located in Taft, Louisiana. Site enhancements and extension of its Mississippi River pipeline system will allow Air Liquide to provide more efficient gas production and delivery. The construction is expected to be completed in early 2027.
By expanding its robust industrial pipeline network throughout Texas and Louisiana, Air Liquide will also be able to further support its nitrogen and oxygen customers along the Mississippi River with increased flexibility and competitiveness. This stra-
tegic investment will strengthen Air Liquide’s position in the U.S. Gulf Coast and enable future growth opportunities.
Matthieu Giard, Group Vice President, Americas, said: “Air Liquide is proud to extend its long standing relationship with Dow. We strive to provide a safe and reliable gas supply that meets our customers’ needs. By enhancing the overall efficiency of our robust and flexible distribution network, we are taking concrete action in support of that ambition. Air Liquide’s operations in Louisiana are part of the industrial backbone that have supported the development of many industries on the Gulf Coast, and this investment illustrates our commitment to support our customers’ growth.”
After more than 25 years with the NürnbergMesse Group, Stefania Calcaterra stepped down as managing director of its subsidiary NürnbergMesse Italia on 30 June and passed the baton to her successor, Danny D’Alessandro. Calcaterra has successfully headed and rigorously developed NürnbergMesse Italia since it was established in 2009. Under her leadership, Italy consolidated its position as

number one among the international exhibiting countries at the Nuremberg exhibition venue: “Stefania Calcaterra’s departure marks the end of an era, and also the start of a new chapter in our largest exhibiting country. Our thanks go to Stefania for more than 25 years of tireless effort, passion, foresight and commitment,” says Dr. Thomas Koch, Chairman of the Annual Shareholders‘ Meeting of NürnbergMesse Italia.
Stefania Calcaterra worked as international representative in Italy for NürnbergMesse and also for Spielwarenmesse eG from as early as 1999. With her passion for trade fairs and a deep understanding of service quality, she developed NürnbergMesse Italia into an essential link between the important Italian trade fair market and the international trade fair community. Her most recent success story is the “Focus on PCB” trade fair. Ever busy in her role as managing director, Calcaterra launched this trade fair during the Covid-19 pandemic and, when in-person trade fairs resumed, very
quickly turned it into a meeting place for the European printed circuit board industry in the Italian city of Vicenza. She will continue to be responsible for this trade fair for a further two years.
Danny D’Alessandro assumed the managing role at NürnbergMesse Italia from 1 July 2025. With qualifications in law and an Executive MBA, D’Alessandro comes with more than 15 years of experience in the trade fair and fashion industries. Most recently he was General Manager at Aimpes Servizi, organizer of Mipel, the international leather and fashion accessories event, where he was responsible for all business-relevant processes. Dr. Thomas Koch, member of the Executive Board, is pleased to welcome the most recent appointee to the NürnbergMesse Group: “With his expertise in heading trade fairs, his international focus and his sense for industry trends, Danny D’Alessandro is the ideal person to take the success story of NürnbergMesse Italia forward and provide new inspiration.”







The Eu Commission Plan addresses key challenges, namely high energy costs, unfair global competition, and weak demand, while promoting investment in innovation and sustainability.
Last July, the European Commission presented an Action Plan for the Chemicals Industry to strengthen the competitiveness and modernisation of the EU chemical sector. The Action Plan addresses key challenges, namely high energy costs, unfair global competition, and weak demand, while promoting investment in innovation and sustainability. The Action Plan is accompanied by a simplification omnibus on chemicals – the sixth that the Commission has presented in this man-
date so far – to further streamline and simplify key EU chemicals legislation, alongside a proposal to strengthen the governance and financial sustainability of the European Chemicals Agency (ECHA).
The Action Plan proposes the following measures: Resilience and level playing field: The Commission will establish together with Member States and stakeholders a Critical Chemical Alliance to address the risks of capacity closures in the sector. The Alliance will identify
critical production sites needing policy support and tackle trade issues like supply chain dependencies and distortions. The Commission will also swiftly apply trade defence measures to ensure fair competition, while expanding chemical import monitoring through the existing Import Surveillance Task Force. The Alliance will align investment priorities, coordinate EU and national projects, including Important Projects of Common European Interest (IPCEIs) and support EU critical production sites to boost
innovation and regional growth. Affordable energy and decarbonisation - The Commission will implement at full speed the Affordable Energy Action Plan to help reduce high energy and feedstock costs. It has introduced clear rules for low-carbon hydrogen and will update state aid to lower electricity costs for more chemical producers by the end of the year. The plan also encourages using clean carbon sources like carbon capture, biomass, and waste, alongside support for renewables. A public consultation on improving chemical recycling has also been launched.
Lead markets and innovation - The Action Plan highlights fiscal incentives and tax measures to boost demand for clean chemicals. The upcoming Industry Decarbonisation Accelerator Act will set EU content and sustainability rules to support market growth and clean technology investment. The upcoming Bioeconomy Strategy and Circular Economy Act will boost the EU’s resource efficiency, chemicals recycling, and strengthen the market for bio-based and recycled alternatives to fossil-based inputs. The Commission will also launch EU Innovation and Substitution Hubs and mobilise EU funding under Horizon Europe (2025–2027) to accelerate the development of safer, more sustainable chemical substitutes.
Taking action on per- and polyfluoroalkyl substances (PFAS) - The Action Plan reaffirms the Commission’s commitment to minimise PFAS emissions through a robust, science-based restriction, while ensuring continued use in critical applications under strict conditions where no alternatives are available which will be proposed swiftly after ECHA’s opinion. The Commission will also invest in innovation, promote remediation based on the polluter pays principle, and prioritise the development of safer alternatives.
As part of its ongoing efforts to boost the EU’s competitiveness, the Commission adopted a sixth simplification omnibus to reduce compliance costs and administrative burden for the chemical industry while ensuring strong protection of human health and the environment. This includes simplifying hazardous chemical labelling rules, clarifying EU cosmetics regulations, and easing registration for EU fertilising products by aligning information requirements with standard Reach rules for chemicals. These measures are expected to save at least €363 million annually for the industry. The proposal for the ECHA Basic Regulation equips ECHA with the resources, flexibility, and structural adaptations required to fulfil the duties under its growing mandate, which now includes responsibilities under multiple EU regulations, namely spanning classification and labelling, biocidal products, import and export of hazardous chemicals, waste management and water. The chemicals sector is vital to Europe’s economy, underpinning the manufacture of almost all goods. It provides essential materials and technologies to industries that support the welfare, security and resilience of European economies, including automotive, construction, healthcare, agriculture, clean technologies and defence.
The European Chemicals Industry Action Plan builds on the Competitiveness Compass and Clean Industrial Deal. Following the President’s Strategic Dialogue on 12 May 2025, it is the Commission’s third sector plan after automotive and steel. The simplification package presented today delivers on President von der Leyen’s commitment to simplify EU laws and cut administrative burdens, helping businesses innovate and grow. Presi-

dent von der Leyen announced a sector-specific omnibus in the first Strategic Dialogue on the future of the Chemical Industry in Europe with representatives of the sector, held on 12 May 2025. The Single Market Strategy adopted in May 2025 reiterated that commitment. The Omnibus for the Chemicals Industry is one of a series of Simplification Omnibus packages presented by the Commission under this mandate. The EU chemical industry is the fourth largest manufacturing sector, with 29,000 companies providing 1.2 million direct jobs and supporting 19 million across supply chains.
“Chemicals is the mother of all industries, with over 96% of manufactured goods relying on chemicals”, said Stéphane Séjourné, Executive Vice-President for Prosperity and Industrial Strategy. “This action plan on chemicals is our business plan to secure this critical sector’s future in Europe. It includes all levers to put the sector back on a growth track, from production-support measures to keep our steam-crackers and chemical sites in Europe, to trade defence instruments to protect our chemical businesses from unfair global competition, all the way to securing domestic demand for clean & ‘made in Europe’ chemicals.”
Stéphane Séjourné, Eu Commission Executive Vice-President for Prosperity and Industrial Strategy

Since June Gergely Sved has been the new Chief Executive Officer (CEO) of Ellab, following the departure of Ludvig Enlund. Mr Sved is a highly experienced healthcare and life sciences executive. Most recently he served as Executive Vice President and Group President for the Healthcare and Life Sciences division at Ecolab Inc, a global leader in water, hygiene and infection prevention solutions and services. At Ecolab, he was
responsible for driving an ambitious growth strategy for the Life Science and Purolife, its Cleanroom, API and Bioprocessing businesses. Previously, he led the expansion of Ecolab’s Endoscopy, Surgical and Infection Prevention businesses – including during the Covid pandemic. Prior to Ecolab, Mr Sved spent 23 years with General Electric in various roles, including most recently at GE Healthcare, where for six years he was Vice President and General Manager Europe Services.
Anders Hedegaard, Chair of Ellab, commented: “Ellab is at a very exciting point in time as we
Ampersand Capital Partners, a private equity firm specializing in growth equity investments in the life sciences and healthcare sectors, announced the acquisition of CurTec Group B.V., a Netherlands-based manufacturer of high-performance plastic packaging solutions for pharmaceutical and specialty chemical applications from Bencis Capital Partners in partnership with management. Headquartered in Rijen, CurTec has manufacturing operations
in the Netherlands and the United States and sales offices across Europe, North America and Asia. CurTec designs and manufactures GMP-compliant, UN-certified packaging solutions engineered for the secure storage and transport of active pharmaceutical ingredients (APIs), excipients and other high-value and sensitive biopharma and chemical ingredients used in regulated environments where cleanliness, compliance and durability are critical.
look to accelerate growth and development of the business. Gergely brings a wealth of relevant experience, and we look forward to working with him as we execute our ambitious growth strategy. We are grateful for Ludvig’s contribution to bringing Ellab to where we are today and wish him well in his onwards career”.
“Ellab is a fascinating business that plays a critical role in ensuring integrated compliance solutions, anchored in its customers’ most critical operations” says Gergely Sved. “It has great products and services, and a highly experienced team, and I am looking forward to working together to help Ellab fulfil its tremendous potential”.
“We are thrilled to welcome Ampersand as our new partner as we focus on scaling U.S. operations, advancing product innovation, expanding our footprint and growing into adjacent markets,” said Bart van Berkel, CEO of CurTec. “Their deep expertise in the life sciences supply chain and their US network will help accelerate our global presence while reinforcing our commitment to quality, innovation, and sustainability.”
“CurTec is a premium brand trusted by leading pharmaceutical companies – including those within Ampersand’s portfolio – for its excep-
Last June, Dow Chemical hosted the Together for Sustainability (TfS) General Assembly at its site in Horgen, Switzerland, bringing together representatives from 57 member companies united in its mission to drive sustainability across global supply chains. The meeting marked an important milestone in this collective journey, as they reviewed progress and aligned on next steps within the Accelerate4Impact strategy – the shared roadmap for increasing impact and scaling sustainable business practices across industries.
The Assembly re-elected Jennifer Jewson (LyondellBasell) as TfS President for a second two-year term. Her leadership continues to be instrumental in guiding the strategy and momentum.
The elected TfS Steering Committee (SteerCo) members are: Bertrand Conquéret, Cathy Budd, Götz Lauschke, Thomas Udesen (re-elected); Matthias Dohrn and JC Fuenmayor (newly elected).
All will serve a 2-year mandate to advance the shared sustainability agenda. Through TfS, procurement becomes a force
tional product quality and regulatory standards,” said Hidde Van Kerckhoven, Principal at Ampersand. “We look forward to working closely with Bart and his team to expand capacity, strengthen commercial capabilities, and support long-term growth.”
“We look back on a very successful partnership with CurTec and the team, evolving into a global leader in regulated packaging through innovation, operational and ESG excellence, and a clear focus on pharma,” said Zoran van Gessel, Managing Partner at Bencis.

for good – shaping more transparent, responsible, and resilient supply chains.
EyeC GmbH, a leading global provider of automated artwork and print image inspection systems, has appointed Matthew Wilkins as its new National Sales Manager for the United Kingdom and Ireland.
In this strategic role, Matthew will oversee all sales operations across the UK and Ireland, with a particular focus on expanding EyeC’s presence and footprint in the region. Upon joining EyeC, he will report directly to Dr Ansgar Kaupp, CEO of EyeC GmbH, and Markus Fietkau, Sales Director.
With over 20 years of international experience in sales and marketing management, Matthew brings a wealth of knowledge from various industries, including Financial Ser-

vices, Digital Media, and Healthcare. His most recent positions have been with the 3M PLC Food Safety Division and the 3M Safety and Industrial Business Group, where he played a pivotal role in expanding market share through strategic collaboration and reliable partnerships with key account clients.
Matthew has a proven track record in delivering customer-focused solutions, leveraging deep market insights to develop best practices and optimize manual systems. His experience also includes supporting clients in automation and robotics, helping them modernize and streamline their operational processes.
Regarding his new position, Mat-
















thew Wilkins said: “EyeC is a dynamic, innovative, and ambitious company. I am looking forward to working with the team to help achieve our future goals and strengthen our presence in the UK and Ireland.”
Founded in 2002, EyeC GmbH provides fast, accurate, and easy-touse artwork and print inspection systems.
EyeC is the only provider on the market that ensures product quality throughout the entire manufacturing process – from the first artwork file to the finished printed product. Products from EyeC provide users with 100% confidence about the print quality of their products, such as labels, folding boxes, package inserts, or flexible packaging.




The solution for your compliance with international standards
Comprehensive and intuitive instruments for online and portable measurements of TOC, conductivity and ozone.
Global Compliance and International Standards
• Complies with FDA 21 CFR Part 11, EMA Allegato 1 and 11, and international pharmacopoeias (USP, Ph. Eur., ChP, JP).
• Designed according to GMP, GAMP ® , ASTM, ISO, and ISPE to meet the highest expectations of the industry.
Secure Data and Simpli ed Management
• Multi-level user management with electronic signatures.
• Complete history and meta data according to ALCOA+ principles.
• Tamper-proof control for process security.
Swan Analitica Srl ∙ IT-16167 Genova www.swananalitica.it ∙ swan@swananalitica.it





Maziar Mike Doustdar:
“From my decades in leadership roles across Novo Nordisk, I know the extraordinary talent and commitment of our people and the excellence of our science.”
Novo Nordisk announced that Maziar Mike Doustdar has been appointed as president and chief executive officer, effective 7 August 2025. Mike Doustdar succeeds Lars Fruergaard Jørgensen, who will step down as president and chief executive officer on the same date. The company also announced other executive-level changes, effective 7 August. Mike Doustdar, currently Novo Nordisk’s executive vice president of International Operations, has a strong track record of creating value and driving growth. Under his leadership over the past decade, Novo Nordisk’s International Operations have more than doubled sales to approximately DKK 112 billion in 2024. The business includes all of Novo Nordisk’s affiliates outside of the US and employs nearly 20,000 people.
Novo Nordisk Chair, Helge Lund, said: “Mike is an exceptional leader and has the unanimous support of the Board. We are confident that he is
the best person to lead Novo Nordisk through its next growth phase. Mike has consistently demonstrated the ability to drive growth through strong commercial execution and building high-performing teams. This is an important moment for Novo Nordisk. The market is developing rapidly, and the company needs to address recent market challenges with speed and ambition. I believe Novo Nordisk will build on its strengths as a global leader in obesity and diabetes, and Mike has a clear vision of how to unlock the full potential of the opportunities ahead.”
Mike Doustdar has been appointed as the result of a comprehensive process that included external and internal candidates. The Novo Nordisk Foundation fully endorses Novo Nordisk Board’s decision to appoint Maziar Mike Doustdar as president and chief executive officer. Mike Doustdar said: “It’s an enormous privilege to lead this company at a time of
tremendous opportunity and change. I come to this role with a sense of urgency, a laser focus on high performance, and a fierce determination for Novo Nordisk to aim higher than it’s ever done, and to deliver to many more patients the innovation they need. From my decades in leadership roles across Novo Nordisk, I know the extraordinary talent and commitment of our people and the excellence of our science. This has enabled us to achieve great things in the past and will ensure we continue to do so in the future.”
Novo Nordisk Chair, Helge Lund, added: “Under Lars’s leadership, Novo Nordisk has undergone a profound period of growth and now reaches millions more patients with life-changing medicines. On behalf of Novo Nordisk’s Board of Directors and our employees, I want to thank Lars for 34 years of unstinting commitment to the company and wish him all the best in his future endeavours.”
Coesia, a global leader in advanced industrial and packaging solutions, has announced the acquisition of the majority capital of Autoware, an international Manufacturing Software Integrator based in Vicenza, specialized in high-quality software for manufacturing operations management, supply chain operations and process control.
Its portfolio includes Manufacturing Execution Systems (MES), Manufacturing Operations Management (MOM) software, and Supervisory Control and Data Acquisition (SCADA) solutions for leading companies, mostly but not limited to those in the Food & Beverage, Consumer Packaged Goods, and Pharmaceutical sectors.
“This acquisition marks another important steppingstone in Coesia’s digital transformation journey, reinforcing our commitment to leading the Industry 4.0 evolution. By integrating Autoware’s deep digital expertise with Group’s
extensive industry knowledge, we are expanding our ability to deliver seamless, end-to-end solutions that enhance efficiency, foster innovation, and meet the rapidly evolving needs of manufacturers worldwide. This move accelerates our vision of becoming a global leader in smart manufacturing solutions.”, says Alessandro Parimbelli, CEO of Coesia.
“Partnering with Coesia is a significant opportunity to establish a truly global platform and broaden our reach into new geographies and markets. The Group’s extensive customer portfolio across key industries will further accelerate Autoware’s growth in continuity with the existing strategy, while maintaining our commitment to delivering high-quality solutions for digital transformation in manufacturing”, states Luigi De Bernardini, CEO and founder of Autoware.



The pharmaceutical industry is a key asset to scientific and medical progress. The research-based pharma can play a critical role in restoring Europe to growth and ensuring future competitiveness in an advancing global economy.
Thanks to advances in science and technology, the research-based pharmaceutical industry is going through an exciting era in medicines development. Research methods are evolving and we have many promising prospects on the horizon, with ground-breaking cell and gene therapies being increasingly available. The innovative pharmaceutical industry is driven by, and drives, medical progress. It aims to turn fundamental research into innovative treatments that are wide-
ly available and accessible to patients. Already, the industry has contributed to significant improvements in patient well-being. Today’s European citizens can expect to live up to 30 years longer than they did a century ago. Some major steps in biopharmaceutical research, complemented by many smaller steps, have allowed for reductions in mortality, for instance from HIV/AIDS-related causes and several cancers. High blood pressure and cardiovascular diseases can be controlled with antihypertensive and cholester-
ol-lowering medicines; knee or hip replacements prevent patients from immobility; and some cancers can be controlled – or even cured – with the help of new targeted treatments. European citizens can expect not only to live longer, but to live better quality lives. Yet major hurdles remain, including Alzheimer’s, Multiple Sclerosis, many cancers, and rare diseases.
A key asset to the european economy As well as driving medical progress by researching, developing and bringing
new medicines that improve health and quality of life for patients around the world, the research-based pharmaceutical industry is a key asset of the European economy. It is one of Europe’s top performing high-technology sectors. The research-based pharmaceutical industry can play a critical role in restoring Europe to growth and ensuring future competitiveness in an advancing global economy. In 2024 it invested an estimated € 55,000 million in R&D in Europe. It directly employs some 950,000 people and generates about three times more employment indirectly – upstream and downstream – than it does directly (PwC, Economic and societal footprint of the pharmaceutical industry in Europe, November 2024). However, the sector faces real challenges. Besides the additional regulatory hurdles and escalating R&D costs, the sector continues to be hit by the impact of fiscal austerity measures introduced by governments across much of Europe since 2010. There is rapid growth in the market and research environment in emerging economies such as Brazil, China and India, leading to a gradual migration of economic and research activities from Europe to these fast-growing markets. During the period 2019-2024 the Brazilian, Chinese and Indian markets grew by 14.3%, 2.2% and 9.5% respectively compared to an average market growth of 7.9% for the top 5 European Union markets and 9.8% for the US market (source: IQVIA MIDAS, May 2025). In 2024 North America accounted for 54.8% of estimated world pharmaceutical sales compared with 22.7% for Europe. According to IQVIA (MIDAS May 2025), 66.9% of sales of new medicines launched during the period 2019-2023 were on the US market, compared with 15.8% on the Eu-ropean market (top 5 markets). The fragmentation of the EU pharmaceutical market has resulted in a lucrative parallel trade. This benefits nei-
EFPIA (The European Federation of Pharmaceutical Industries and Associations) represents the research-based pharmaceutical industry operating in Europe. Founded in 1978, its members comprise 36 national pharmaceutical industry associations, 40 leading pharmaceutical companies and 13 small and medium sized enterprises undertaking research, development and manufacturing of medicinal products in Europe for human use. EFPIA aims to create an environment that enables its members to innovate, discover, develop and deliver new therapies and vaccines for people across Europe, as well as contribute to the European economy. EFPIA’s vision is for a healthier future for Europe. A future based on prevention, innovation, access to new treatments and better outcomes for patients.
As well as driving medical progress by researching, developing and bringing new medicines that improve health and quality of life for patients around the
As well as driving medical progress by researching, developing and bringing new medicines that improve health and quality of life for patients around the
Through its membership, EFPIA represents the common views of about 1,900 large, medium and small companies including the entire European research-based pharmaceutical sector whose interests also include a significant part of the generics and biosimilars segments. Vaccines Europe (VE) is the specialised vaccine industry group within EFPIA. It represents major innovative research-based global vaccine companies as well as small and medium sized enterprises operating in Europe.
world, the research-based pharmaceutical industry is a key asset of the European economy. It is one of Europe’s top performing high-technology sectors.
world, the research-based pharmaceutical industry is a key asset of the European economy. It is one of Europe’s top performing high-technology sectors.
Values in € million unless otherwise stated
(1) Data relate to EU-27, Norway, Switzerland and United Kingdom since 2005 (EU-15 before 2005); Croatia and Serbia included since 2010; Turkey included since 2011
Values in € million unless otherwise stated
(1) Data relate to EU-27, Norway, Switzerland and United Kingdom since
(2) Data relating to total exports and total imports include EU-27 intra-trade (double counting in some cases)
and Serbia included since
Source: EFPIA member associations (official figures) - (e): EFPIA estimate; Eurostat (EU-27 trade data 2000-2024)
- by the time a medicinal product reaches the market, an average of 12-13 years will have elapsed since the first synthesis of the new active substance;
Note:
Note:
The figures relate to the R&D carried out in each country. Poland, Slovenia, U.K.: 2022 data; Austria, Netherlands: 2021 data; Hungary, Slovakia, Turkey: 2020 data; Norway: 2015 data; Cyprus, Ireland: 2013 data; Croatia: 2011 data Belgium, Croatia, Denmark, France, Greece, Ireland, Italy, Netherlands, Norway (LMI members), Romania, Slovenia, Sweden, Switzerland (Interpharma members), Turkey: estimate
The figures relate to the R&D carried out in each country. Poland, Slovenia, U.K.: 2022 data; Austria, Netherlands: 2021 data; Hungary, Slovakia, Turkey: 2020 data; Norway: 2015 data; Cyprus, Ireland: 2013 data; Croatia: 2011 data Belgium, Croatia, Denmark, France, Greece, Ireland, Italy, Netherlands, Norway (LMI members), Romania, Slovenia, Sweden, Switzerland (Interpharma members), Turkey: estimate
Source: EFPIA member associations (official figures)
EMPLOYMENT IN THE PHARMACEUTICAL INDUSTRY (1995-2024)
EMPLOYMENT IN THE PHARMACEUTICAL INDUSTRY (1995-2024)
Source: EFPIA member associations (official figures)


Note:
Note:














Data includes Iceland (since 2017), Croatia, Lithuania and Turkey (since 2010), Bulgaria, Estonia and Hungary (since 2009), Czech Republic (since 2008), Cyprus (since 2007), Latvia, Romania & Slovakia (since 2005), Malta, Poland and Slovenia (since 2004)
Data includes Iceland (since 2017), Croatia, Lithuania and Turkey (since 2010), Bulgaria, Estonia and Hungary (since 2009), Czech Republic (since 2008), Cyprus (since 2007), Latvia, Romania & Slovakia (since 2005), Malta, Poland and Slovenia (since 2004)
Source: EFPIA member associations (official figures) - (e): EFPIA estimate
Source: EFPIA member associations (official figures) - (e): EFPIA estimate
EMPLOYMENT IN PHARMACEUTICAL R&D (1995-2024)
EMPLOYMENT IN PHARMACEUTICAL R&D (1995-2024)






Note:

The importance of Research and Development

ther social security nor patients but deprives the industry of additional resources to fund R&D and leads to supply dis ruptions on several smaller markets. Par allel trade was estimated to amount to € 6,497 million (value at ex-factory prices) in 2023.








All new medicines introduced into the market are the result of lengthy, costly and risky research and development (R&D) conducted by pharmaceutical companies:
- the cost of researching and developing a new chemical or biological entity is estimated at € 3,130 million ($ 3,296 million in year 2022 dollars) in 2022 applying the methodology used by Joseph A. DiMasi in his 1991, 2003 and 2016 Tuft Center for the Study of Drug Development studies (Wild, C. and Fabian, D. (2024), AIHTA, The Role of Public Contributions to the Development of Health Innovations, HTA-Projektbericht 158). On average, only one to two of every 10,000 substances synthesised in laboratories will successfully pass all stages of development required to become a marketable medicine. In 2023 the pharmaceutical industry invested about € 52,400 million in R&D in Europe. A decade of strong US market dominance led to a significant shift of economic and research activity towards the US during the periods 19952005 and 2015-2020, a trend that has been somewhat slowing down following the Covid pandemic. Additionally, Europe is now facing increasing competition from emerging economies: rapid growth in the market and research environments in countries such as China are contributing to the move of economic and research activities to non-European markets. In 2024 China outpaced both US and Europe as originators of new active substances launched for the first time on the world market. In 2024, out of a total of 81 new molecules, 28 originated from Chinese (including Hong Kong) headquartered companies whilst 25 and 18 originated from US and European headquartered companies respectively. After having lost its crown as the top innovation region in the world in 2000, Europe is now on the third place on the podium as originator of new molecules.


Our passion for screening was conceived at the end of the 1970s.
We have always demonstrated intuition and enthusiasm, thanks to which we have successfully established ourselves in the world of screening.
Our way of working is characterised by a high level of flexibility, which allows us to obtain significant immediate results.
Direct contact with customer issues constantly stimulates our planning
We offer an absolute guarantee of quality, and we have always guaranteed optimum operation of the vibrating screen made ad personam
We are a 100% Made in Italy company; every one of our vibrating screens is entirely made inhouse.
Our vibrating screens are able to cope with very difficult screening and high hourly flow rates, thanks to the special vibrating motors installed, designed to operate continuously 24 hours a day, 365 days a year.

EMILOS srl Via della Costituzione, 6 42025 Cavriago (RE) - Italy Tel. 0522 575010
E-mail: info@emilos.it www.emilos.it



Generics and biosimilars are usually produced by a manufacturer who is not the inventor of the original chemical or biological substance. They can be marketed after expiry of the intellectual property



















protection rights of the innovative product. Data might not be strictly comparable across countries due to differences in procurement and reimbursement practices.
SHARE (ESTIMATE - IN %) ACCOUNTED FOR BY GENERICS IN PHARMACEUTICAL MARKET SALES VALUE (AT EX-FACTORY PRICES), 2023
Note:
Bulgaria, Croatia, Czech Republic, Denmark, Estonia, Finland, Hungary, Netherlands, Slovenia, U.K.: share of generics in pharmacy market sales
Austria, Belgium, Cyprus, France, Germany, Greece, Italy, Portugal, Spain: share of generics in reimbursable pharmacy market sales
Ireland, Latvia, Lithuania, Luxembourg, Norway, Poland, Romania, Serbia, Slovakia, Sweden, Switzerland, Turkey: share of generics in total market sales
Lithuania: 2020 data; Cyprus, Iceland, Malta: data not available
France: data relate only to those active substances listed on the official list of medicines
Source: EFPIA member associations
The North American market remained the world’s largest one
The world pharmaceutical (prescription) market was worth an estimated € 1,413,609 million ($ 1,528,535 million) at ex-factory prices in 2024. The North American market (USA & Canada) remained the world’s largest market with a 54.8% share, well ahead of Europe, China and Japan.
Distribution margins, which are generally fixed by governments, and VAT rates differ significantly from country to country in Europe. On average, approximately one third of the retail price of a medicine reverts to distributors (pharmacists and wholesalers) and the State.
Generics and biosimilars
Generics and biosimilars are usually produced by a manufacturer who is not the inventor of the original chemical or biological substance. They can be marketed after expiry of the intellectual property protection rights of the innovative product. Data might not be strictly comparable across countries due to differences in procurement and reimbursement practices.
The added value of medicines in healthcare
Medicines constitute the smallest part of healthcare costs with, on average, 17.4% of total health expenditure in Europe being spent on pharmaceuticals and other medical goods. In costly diseases such as cancer and rheumatoid arthritis, medicines account for less than 20% of the total disease costs. Medicines can also generate additional savings, for example by substantially reducing costs in other areas of healthcare, including hospital stays and long-term care costs.
Source: EFPIA - European Federation of Pharmaceutical Industries and Associations
| Read More



In the pharmaceutical packaging market, AI and patients choiches are becoming increasingly central and decisive, driving the development of smart, personalized, and sustainable solutions.
In 2025 and the years to come, the pharmaceutical packaging sector is bracing for marked changes and opportunities for all. By the end of 2025, the packaging market for the broader healthcare industry is expected to reach US$159 billion, with predictions putting the value at nearly US$400 billion within the next decade. The pharmaceutical packaging industry plays a pivotal role in the larger healthcare market, ensuring product safety, integrity, and efficacy. As the pharmaceutical industry contends with incoming regulations on sustainability and consumer demands for therapeutics including GLP-1 agonists and innovative treatments, pharmaceuti-
cal packaging will be at the forefront of new ideas and products. The Trend Report “2025 Pharmaceutical Packaging Market Prospects” by CPHI explores the biggest trends affecting the pharmaceutical packaging sector, with a particular focus on the therapeutics demanding innovation and creativity in delivery and packaging. Continuing discussions around meeting sustainability objectives and partnership demands are also influencing the sector’s activities in ways that are changing the industry as a whole.
The pharmaceutical industry is seeing an unprecedented moment
in history where consumer-driven demands are shaping the priorities of the pharmaceutical supply chain. Pharmaceutical companies are now looking for packaging solutions for all kinds of innovative drug products to meet consumer demand.
Increasing demand for certain blockbuster therapeutics, sustainability concerns, and drug delivery devices geared towards specific patient populations like geriatric patients and accessible designs are forcing pharmaceutical companies to take their therapeutic packaging considerations into account at the start of their drug development pipelines.
Top therapeutics demand packaging innovation
While sustainability and ESG practices are a continuing factor driving corporate decision making, patient considerations are now also playing a bigger role in dictating the packaging market. Now, a major driver for new forms of packaging is the response to increasing demand in particular therapeutics.
“What we are seeing in the industry today is a focus on bio-therapeutics (biologics and biological products)”, explains Asmita Khanolkar, Senior Director at SMC Ltd. “A lot of these biological products are complex formulations with special storage and delivery requirements. With injectables in mind, delivery is typically via devices and the stability of biologics requires cold chain storage. This requires a different type of packaging strategy, including a patient-centric approach for self-administration ease. This is causing a shift from standard, off-the-shelf available packaging (that may not meet requirements) to a more strategic packaging solution for the biologics pipeline, cold chain management, and transport logistics. Another item to consider is the focus on ‘one size does not fit all’ approach. Unlike the blockbuster drug launches of the past, with targeted therapies and personalised medicines, patient populations tend to be much smaller. The cost-toscale effectiveness and subsequent longterm therapy costs must be balanced with meeting the patient needs. There are a number of new nuances to consider when planning packaging strategies around biologics, personalised medicine, targeted therapies, selfadministration, targeted populations that relatively smaller, and small-batch manufacturing”.
Pharma 5.0 and packaging success
The digitisation of the pharmaceutical supply chain remains a hot topic for all in the industry – and pharmaceutical packaging is no exception. While automation in the pharmaceutical packaging realm is nothing new, the surge in technologies around artificial intelligence and deep machine learning are bringing new awareness to how technology can further innovation in pharma packaging. Importantly, AI-support digital technologies can also help support both patients and companies.
“The pharmaceutical packaging and drug delivery device sectors can leverage digital technologies and AI in several ways to drive innovation and enhance patient support”, adds Lewening. “Smart packaging for enhanced patient adherence; AI-powered supply chain optimization; personalized and patient-centric packaging; advanced drug delivery devices; sustainability and waste reduction”.
Delivering on sustainability initiatives
Sustainability in the pharmaceutical packaging sector continues to be an ongoing discussion. Whether it is implementing the measures promised, recording and reporting to keep each other accountable, or even knowing where to start, it is more important now than ever for pharmaceutical companies and their partners to flesh out their sustaina-

bility strategies for business success. “Some of the biggest challenges faced by the pharmaceutical packaging and drug delivery device companies are around sustainability and regulatory pressures”, states Lengwe Sinkala, a Human Factors and UX Consultant at ClariMed, Inc. “The pharmaceutical industry faces increasing environmental regulations and pressure to reduce single-use plastics and carbon emissions. For example, prefilled syringes, inhalers, and autoinjectors generate medical waste and pose recycling challeng-
The pharmaceutical industry is seeing an unprecedented moment in history where consumerdriven demands are shaping the priorities of the pharmaceutical supply chain
The surge in technologies around artificial intelligence and deep machine learning are bringing new awareness to how technology can further innovation in pharma packaging

es. EU and US sustainability laws demand ecofriendly alternatives, such as France’s ban on certain plastic packaging for medical use”.
Initiatives such as the UK’s Extended Producer Responsibility (EPR) are also being put into place to force organisations responsible for packaging to take accountability for the recyclability and lifecycle of their packaging products. Regulations such as these, while a socially responsible step in the right direction, can also provide difficult challenges for companies affected.
“Stricter global regulations, such as the EU Green Deal, PPWR, and Extended Producer Responsibility laws, are pushing companies toward sustainable materials and reducing plastic waste”, Lewening comments.
“Developing fully recyclable packaging that still meets strict pharma requirements, however, is complex. Compliance with different regulations that frequently updated demand constant adaptation in packaging design and validation, while shortages in plastics,aluminium, and glass due to geopolitical issues or energy crises and impact the cost

of transportation, constrain supply chains, and impact pricing and profitability”.
Regional policies and shifting priorities for packaging
Discussions of pharmaceutical contract organisations in 2025 cannot be had without mentions of the US Biosecure Act, first proposed in December 2023, approved by Senate and House committees throughout 2024, and passed by the House of Representatives in September 2024. While the Act specifically targets pharmaceutical manufacturers based in China, the wider implications for the pharmaceutical supply chain also holds packaging and drug delivery device companies in anticipation.
“When you look at flexible packaging, this used to be a market that was truly global 10-15 years ago”, explains von Kienlin, Consulting Managing Director of L.E.K. Consulting. “You could produce anywhere and ship anywhere. With oil and gas prices through the roof now, it is not so much the case anymore. Companies are now sourcing much closer due to prohibitive costs – this is just one example where the cost of logistics in shipping has prompted a regionalisation of markets”.
“There’s quite a lot of varying regulations for waste management across countries, which creates further fragmentation”, states Edgar Pogna, Director, Life Science L.E.K. Consulting. “While there are some truly innovative packaging solutions that may seem like they have a competitive advantage, they might only work in an environment where waste is managed in a certain way, for example, how sample films are separated from blisters, or dismantling of injection pens. Even within Europe, there are differences in how this is regulated, creating further compli-

Patient-centricity in particular is at the forefront of innovative packaging opportunities
cations in managing logistics and supply chains”.
The future of industry collaborations for pharma packaging success With M&A activity dominating industry news for pharma in 2024, some are anticipating continuing collaborative deals or further amalgamations of some of the biggest players in the industry, including packaging companies. Packaging companies that saw landmark mergers or acquisitions include that between Smurfit Kappa and WestRock and Amcor’s purchase of Berry Global. While not pureplay pharmaceutical packaging companies, the sector can expect such partnerships to continue shaping how packagers are integrated to help the industry achieve innovation, sustainability, and business goals.
Patient-centricity in particular is at the forefront of innovative packaging opportunities, particularly with ageing populations across the globe demanding accessible packaging options for their medications.


AGENTI FILMANTI - DISGREGANTI - LUBRIFICANTI - GLIDANTI
- LEGANTI - DILUENTI - OPACIZZANTI - AMIDI E DERIVATIPOLIALCOLI - ZUCCHERI - DOLCIFICANTI - VISCOSIZZANTICONSERVANTI - CORRETTORI DI PH - ANTIAGGLOMERANTI - PRINCIPI ATTIVI - PLASTICIZZANTI
Gli eccipienti e le materie prime distribuite da Faravelli ti aiutano a raggiungere la formulazione farmaceutica perfetta, proprio quella che stai cercando: funzionale, sicura, efficace, performante. La formula che rende ogni cliente soddisfatto e felice.
“Accompagniamo con competenza globale e sensibilità locale i nostri partner verso scelte innovative, per formulare il futuro con ingredienti e soluzioni affidabili e sostenibili”.
With Powtech Tecnopharm, the Nuremberg exhibition grounds again become the hub where everything revolves around technologies for processing powders, solids and liquids.
From 23 to 25 September 2025, the Nuremberg exhibition grounds will again become the hub where everything revolves around technologies for processing powders, solids and liquids. Visitors can already look forward to their old favourites as well as some new ideas and concepts. Participants will also benefit from the co-location with Fachpack, the European Trade Fair for Packaging, Technology and Processes. Partec, the prestigious international scientific congress, will be held alongside Powtech Technopharm again in 2025.
A new feature this year is that Powtech Technopharm will now occupy Halls 9 to 12 in the northwest grounds of the exhibition centre. This area is readily accessible directly from the underground station or coming from the eastern section of the grounds through the exhibition park, where live demonstrations of explosions will be held again this year. Many visitors are sure to also benefit from a tour of the other exhibition halls, where Fachpack will simultaneously be showcasing current and future packaging solutions. The Powtech Technopharm
ticket also gives visitors access to Fachpack. “The feedback we are getting from all parties is that the entire processing community is already looking forward to the exhibition again. People have gradually got their heads around the new cycle – two consecutive years of Powtech Technopharm every September, followed by a break in the third year – which makes it easier for people to plan,” says Marianny Eisenhofer, Director of Powtech Technopharm, of the status quo around six months ahead of the event. “In terms of international presence, we are also already making good progress. And with the new Processing Alliance, we will be focusing even more strongly in future on building business relationships in international markets.”
The Processing Alliance of NürnbergMesse GmbH is an international network of leading events for the global processing community that aims to address trends in the respective markets worldwide and focus even more specifically on customer benefits.
Spotlight on pharma Extending the brand to Powtech Technopharm lives up to the new

claim “Your Destination for Processing Technology” and puts the spotlight on the pharmaceutical and life sciences industry, especially GxP-compliant manufacturing of liquid, semi-solid and solid pharmaceuticals. The supporting organisation APV (International Association for Pharmaceutical Technology) is honorary sponsor. The Technopharm Forum has been set up specifically to showcase in Stage Talks the various segments of the pharmaceutical industry. At the new “Pharma-in-Focus” pavilion, companies will present specific products and solutions to the high-calibre professional audience with relatively little effort but significant impact.

Supporting programme offers balanced blend of old and new At the September 2025 event, the supporting programme for Powtech Technopharm will include familiar features and new concepts. Alongside the Technopharm Forum, the popular Powtech Forum gives companies another opportunity to present themselves and their innovative solutions to an interested audience. The Call for Papers has already been launched and is available on the website. A proven and familiar feature is the special show by the VDMA – a long-standing partner to Powtech Technopharm – which will also be part of the supporting programme this year. Organised by the VDMA’s
Air Handling Technology and Processing Technology and Equipment associations, it will feature presentations by companies under the banner “Experience the process chain of the bulk solids industry first-hand”. The Networking Pavilion will once again offer established market players and newcomers the opportunity to take part in the trade fair without overstretching their resources. A new addition to the programme is the inaugural meeting of the “Women4Processing” network for women working in the processing industry. The aim is to give women a platform where they can share knowledge and ideas, learn from one another, and provide mutual support. Women working in processing technology will also benefit from dialogue with the participants of “Women4Packaging”, a similar network organised by Fachpack.

Koeln Parma Exhibitions (KPE), a joint venture of Koelnmesse and Fiere di Parma, launches the first edition of Labotec, the new event entirely concerned with technologies, solutions and services for laboratories and analysis, coming up in Parma – Italy on 28 and 29 October 2025 to promote business opportunities, networking and development for research in Italy. Labotec welcomes exhibitors including producers and distributors

of instrumentation for laboratories, contractor laboratories and service suppliers. The event’s highly qualified visitors, including laboratory directors and managers, quality managers, researchers and scientists, will represent all fields of manufacturing industry (food and beverage, pharmaceuticals, chemicals, cosmetics, life sciences and biotechnologies, environment, livestock farming) as well as medical and care facilities, public sector organisations and research institutes and organisations. In line with its primary mission of underlining and restoring the centrality of the complex role of scientific research in Italy, Labotec offers a stage for a series of projects and special areas that will enrich participants’ experience and make the event an ideal hub for exchanging knowledge. These will include LabWorld Arena, organised in collaboration with partner LabWorld. it, hosting conferences and work-
shops focusing on strategic topics of current importance in the field and addressing issues such as competencies and innovative management in the lab, automation and artificial intelligence, advanced analytics, sustainability and green labs, and the trends and potential of investment in research. A special Startup Area will open a window on innovative trends with a true treasure chest of pioneering ideas and projects underway all over Italy, drawing on the experience of visionary startups. Another highly interactive section will be the Demo Area presenting real and virtual demonstrations of cutting-edge technologies. There will be plenty of opportunities for networking and job placement thanks to the Talent Academy project, aimed at establishing initial contact between companies in the field and highly qualified young talents in order to promote their integration into the world of work.
Dechema, which organises the Achema, the leading trade show for the global process industry, launches Achema Middle East in Saudi Arabia together with Messe Frankfurt. Dechema and Messe Frankfurt have reached the necessary agreements and the event will be held for the first time in Riyadh in 2026, and then every three years after that. Achema Middle East is supported by the Ministry of Industry and Mineral Resources of the Kingdom of Saudi Arabia. This is against the backdrop of Saudi Vision 2030, the ambitious government programme for economic and social development. With Achema Middle East, there will be a new industry meeting place for the process industry in the region, bringing together compa-
nies, political decision-makers and experts to showcase and discuss the very latest developments, technologies and innovations. The event organisers are aiming to attract as many as 400 international exhibitors. The trade show will be accompanied by an extensive congress programme.
As Dr Björn Mathes, CEO of Dechema Exhibitions, explains: “With Messe Frankfurt, we have found a strong partner who shares our vision of further expanding Achema internationally, moving into new markets and adding new, future-oriented elements to our programme. Messe Frankfurt brings its vast expertise in the international trade show business and its worldwide network to the table. At the same time, we contribute our
in-depth sector knowledge and technological expertise from the chemical, pharmaceutical and biotechnology industry – not to mention the experience and community that comes from organising Achema for over a hundred successful years. This opens up excellent opportunities for us to firmly establish Achema Middle East and to reach a global audience there.”
Messe Frankfurt CEO Wolfgang Marzin adds: “We are very proud that Dechema has been holding its leading event for the chemical industry at our Frankfurt base for 88 years. This is why we are especially pleased to join forces with Dechema in setting up Achema Middle East and to launch this renowned brand in a whole new region.”

Where safety isn’t optional: tailor-made environments for pharma with guaranteed contamination control

Engineering | Design | Planning | Construction & Commissioning
Equipment & Validation | Turnkey | Utilities | Equipment
Cables & Piping | Support & Maintenance
Catalyst performance optimization requires more than just technical expertise – it demands a perfect fusion of human knowledge, reliable guidance and cutting-edge technology. Clariant’s Applied Catalyst Technology (ACT) team was built around this mantra.
Lorena Oviol, Head of Applied Catalyst Technology at Clariant Catalysts, unveils how to achieve real impact by maximizing plant performance with catalysts. Her revelations about the fusion of human expertise and cutting-edge technology will prove invaluable for anyone seeking to understand how catalyst optimization offers a competitive advantage. In today’s rapidly evolving chemical industry, where operational efficiency and plant reliability are paramount, catalyst performance optimization re-
quires more than just technical expertise – it demands a perfect fusion of human knowledge, reliable guidance, and cutting-edge technology. Clariant’s Applied Catalyst Technology (ACT) team was built around this mantra, offering dependable, expert support that builds lasting partnerships with customers. While advanced digital solutions drive operational excellence, it’s the team’s hands-on guidance and deep understanding of each customer’s specific challenges that truly set ACT apart. The team serves as trusted advisors who
combine their technical expertise with proven methodologies and advanced digital tools, helping prevent costly downtimes and maximize operational value in an increasingly competitive marketplace.
How does the ACT team combine expertise and innovative solutions to improve catalyst performance throughout the lifecycle?
“The ACT team takes pride in delivering value that extends beyond technical support. By integrating decades

of human expertise with sophisticated digital solutions like CLARITY™, we develop a comprehensive understanding of each catalyst’s lifecycle. This holistic approach enables us to create tailored solutions that precisely match our customers’ operational requirements. What distinguishes our methodology is our commitment to comprehensive lifecycle management rather than focusing on isolated performance metrics. Our team of skilled professionals collaborates with advanced models and platforms to continuously monitor, enhance, and optimize catalyst performance. This integrated approach ensures our customers receive comprehensive solutions, rather than just technical troubleshooting.”
Can you elaborate on the importance of global-local expertise synthesis, and how programs like the Clariant Catalyst Institute (CCI) contribute to this fusion?
“The power of our global-local approach lies in its ability to deliver the best of both worlds. We have strategically positioned five regional teams across the globe, ensuring that our customers receive support that’s both world-class and locally relevant. The Clariant Catalyst Institute (CCI) plays a crucial role in this synthesis by equipping and empowering our talented engineers, account managers, and R&D scientists through comprehensive catalyst training. This ongoing development ensures our teams maintain industry excellence standards.
Our local teams understand the specific challenges and requirements of their regions, while our global network ensures that innovations and best practices are shared across all locations. This structure allows us to be responsive to local needs while maintaining consistent, high-quality standards worldwide. Through the CCI’s development programs, we ensure our customers work
with the most qualified catalyst solutions team capable of optimizing performance, efficiency, and sustainability. The CCI’s continuous training and development opportunities keep our teams at the forefront of catalyst technology, enabling us to provide consistent, reliable service.”
How does Clarity exemplify the combination of human expertise and innovative technology for enhancing performance?
“The integration of our digital service portal Clarity with ACT team’s extensive expertise has transformed the way we deliver value to our customers. By incorporating Navigance’s capabilities, we’ve created a unique position in the market to deliver optimized solutions that enhance customer interactions and operational outcomes. In an environment of increasing industrial competition, our combination of advanced tools and data-driven analytics empowers customers to maintain their competitive advantage.
The real-world impact of Clarity is evidenced through customer feedback across various chemical industries. Plant managers and technical officers from global chemical companies have praised the platform’s ability to display catalyst operations in real-time, monitoring critical parameters like pressure drop and hotspot locations.”
In what ways does the ACT team integrate expertise and advanced solutions to contribute to Clariant’s safety goals?
“In the ACT team, we prioritize looking out for each other while implementing comprehensive safety practices in our daily operations. This approach ensures that safety standards are well integrated into our work, driving continuous improvement in how we operate.
Our team regularly shares safety
learnings and best practices, helping to build and reinforce a strong safe ty culture. Through regular safety re views and discussions, we ensure that safety remains a top priority in our daily work. When optimizing catalyst performance, we operate within de fined safety parameters and en courage open communication about safety concerns and im provements.”
This commitment to safety ex tends to how we work with our customers, sharing rel evant safety insights and promoting responsible op erational practices.”
How does ACT set Clariant Catalysts apart by going the extra mile beyond technical service to become a trusted partner?

“What truly sets us apart is our commitment to being more than just a service provider – we aim to be a trusted partner in our customers’ success. This partnership approach is embedded in everything we do, from our global-local presence to our investment in cutting-edge digital solutions like Clarity.
We firmly believe that by working together, we can maximize the promise of our customer’s technology. Our approach combines lifetime coverage of catalyst performance with state-of-theart digital platforms and tools, all supported by our global network of reliable experts.
The future of catalyst technology requires this powerful synthesis of expert service and cutting-edge solutions. At Clariant, we’re committed to continuously evolving this synthesis to generate increasing value for our customers, setting new benchmarks in technical service delivery and customer collaboration.”
Source: https://www.clariant.com/en/ Corporate/Blog
Eli Lilly and Company announced results from the longterm extension (LTE) of the Phase 3 TRAILBLAZER-ALZ 2 study showing that participants treated with Kisunla (donanemab-azbt) demonstrated slowing of decline, a benefit that continued to grow over three years compared to an untreated external cohort from the Alzheimer’s Disease Neuroimaging Initiative (ADNI).
Participants in the study who started treatment later still saw benefit. However, earlier initiation of Kisunla in study participants significantly reduced the risk of progression to the next stage of the disease compared to those who received Kisunla treatment later. These data were shared as a late breaking 2025 Alzheimer’s Association International Conference (AAIC) presentation in Toronto.
“The TRAILBLAZER-ALZ 2 long-term extension reaffirms that Kisunla delivered sustained clinical benefit that continued to increase over three years and a consistent safety profile,” said Mark Mintun, M.D., group vice president, Neuroscience Research & Development, Eli Lilly and Company.
“Participants continued to show meaningful outcomes, re-
FDA has granted 510(k) clearance for Takeda’s devices to simplify HYQVIA administration
Takeda announced that the U.S. Food and Drug Administration (FDA) has granted 510(k) clearance for HyHub™ and HyHub™ Duo, devices for patients 17 years of age and older that allow HYQVIA® [Immune Globulin Infusion (Human), 10% with Recombinant Human Hyaluronidase] to be transferred from vials without using a needle in a home environment or clinical setting. The HYQVIA administration process consists of dual vial units (DVUs) including one vial of immunoglobulin (IG) and one vial of hyaluronidase. HyHub and HyHub Duo, which act as docking stations for these vials, were developed to simplify administration of HYQVIA by reducing the number of steps required to prepare the infusion of two DVUs or more. HYQVIA is a combination of IG and hyaluronidase for facilitated subcutaneous immunoglobulin (SCIg) infusion that is approved for treatment of adults and chil-
dren two years of age and older with primary immunodeficiency (PI) and as maintenance therapy for adults with chronic inflammatory demyelinating polyneuropathy (CIDP) in the United States. Depending on the indication, HYQVIA can be infused up to once monthly (every two, three or four weeks).
“This milestone exemplifies our dedication to advancing innovative solutions that can enhance the treatment administration experience for people who rely on infusions of facilitated immunoglobulin like HYQVIA,” said Kristina Allikmets, senior vice president and head of Research & Development for Takeda’s Plasma-Derived Therapies Business Unit. “We designed HyHub and HyHub Duo, Takeda’s first customized devices for use with a plasma-derived therapy, with input from patients and caregivers, demonstrating our focus on leveraging technology and deep insights to

inforcing the long-term value of early intervention.”
The TRAILBLAZER-ALZ 2 LTE study was a Phase 3, double-blind extension of the original TRAILBLAZER-ALZ 2 trial, evaluating the efficacy and safety of Kisunla in individuals with early symptomatic Alzheimer’s disease. Participants originally treated with Kisunla either continued treatment or were switched to placebo, while those initially on placebo began Kisunla in a blinded manner. An external comparator group from ADNI was used to assess outcomes against a matched, untreated population.
offer a patient-centric ecosystem of support throughout the treatment journey.”
HyHub and HyHub Duo reduce the number of steps required to prepare the IG and hyaluronidase of the HYQVIA infusion by up to half compared to infusing with a pooling bag depending on the device and number of DVUs used.
HyHub and HyHub Duo also reduce the ancillary supplies required to prepare the infusion and a dedicated carrier bag is available for convenience that enables room-to-room mobility.
“For people living with primary immunodeficiency, innovative devices that can help simplify the administration process of their immunoglobulin treatment can be especially meaningful as many require lifelong treatment for their disease,” said Jorey Berry, president and chief executive officer of the Immune Deficiency Foundation.
HyHub and HyHub Duo are intended for use only with HYQVIA and the devices will be available at no additional cost to patients.


The Glastonbury Group at Human Technopole has been awarded a competitive grant as part of the “From Bed To Bench: the way to innovation” funding programme promoted by the Fondazione Regionale per la Ricerca Biomedica (FRRB). The study, funded with 2.000.000 euros, 600.000 of which will go to the Glastonbury group directly, will begin in late 2025 and run for 3 years. The project, entitled “Deciphering and targeting the immunological niche in PDAC”, addresses one of the most pressing challenges in oncology: the limited efficacy of immunotherapies in pancreatic ductal adenocarcinoma (PDAC). While cell-based therapies such as T cell receptor (TCR) or Chimeric antigen receptor (CAR)-T cells have transformed the treatment landscape for blood cancers, their success in solid tumours such as PDAC remains limited
due to the complex and immunosuppressive tumour microenvironment. To overcome this barrier, the Glastonbury Group will integrate spatial multi-omics, single-cell transcriptomics, and innovative machine learning approaches to map the immune landscape of PDAC in unprecedented detail. The ultimate goal is to identify novel therapeutic targets and develop next-generation engineered immune cells with improved efficacy in solid tumours.
Craig Glastonbury explains: “This project is highly interdisciplinary and translational. By leveraging cutting-edge advances in machine learning, single-cell and spatial transcriptomics, we aim to develop novel therapeutics for the treatment of PDAC.“
The project will leverage Human Technopole’s National Facilities for Genomics
and Light Imaging and will be carried out in collaboration with Prof. Renato Ostuni, Prof. Chiara Bonini and Prof. Stefano Crippa at IRCCS San Raffaele. This FRRB collaborative research call aims to promote biomedical research in personalised and precision medicine by fostering partnerships among the Lombardy healthcare system, universities, and research centres. The funded projects focus on the translational cycle “from bedside to bench to bedside”, in which clinical insights guide laboratory research that in turn updates clinical practice to support innovation and continuous improvement in healthcare.
New research from Charles Rivers Associates for EFPIA demonstrates that a voucher system designed to drive research and development (R&D) into new antibiotics would cost Member States 45% less than previously estimated by the European Commission. Antimicrobial resistance (AMR) is one of the world’s most pressing health emergencies. Yet despite the urgent need, private investment in antimicrobial R&D is limited. To prevent bacteria developing resistance to existing treatments, the aim with any new antibiotic is to use it as little as possible - not an attractive proposition for investors. The transferable exclusivity voucher (TEV) is designed to address this challenge by rewarding the discovery of novel antibiotics without requiring upfront public invest-
ment. The voucher allows a developer to defer generic competition on another one of their products for one year, rather than receiving direct payment for their new antibiotic. This incentivises the company to invest in the development of a new antibiotic despite the medical need to limit its use. EFPIA views TEV as part of a broader package of measures needed to address the AMR challenge. This could include subscription models and other pull incentives.
Nathalie Moll, Director-General, EFPIA, said: “AMR affects hundreds of thousands of people in Europe every year. We urgently need new thinking to kickstart R&D. The TEV is an affordable and balanced mechanism for unlocking antimicrobial innovation.”
The European Commission’s 2023 Impact As-
sessment estimated the cost of one TEV at €294 million to EU public payers. The CRA model, which takes account of proposed constraints on how TEVs can be used, estimates the average cost per TEV to be €162 million. The burden of AMR exceeds the cost of a TEV in every Member State. For example, in France, AMR costs are €264.3 million per year – the cost of TEV would be €28 million. AMR is escalating but current market conditions are failing to support new antimicrobial development. AMR causes 670,000 infections and 33,000 deaths each year in the EU. These figures are expected to rise significantly. The economic impact is projected to reach between €180 billion and €680 billion annually by 2050 if no effective action is taken.


We process raw materials for your business.
Precision, reliability, customization. OQEMA SERVICE is the ideal partner for processing solid chemical raw materials. From grinding to repackaging, we offer tailor-made solutions to adapt each raw material to the needs of your industrial production. Rely on our expertise to optimize your processes with efficiency and quality.

After-Biochem: a European flagship project comes to a close, paving the way for sustainable industrial green chemistry.
The After-Biochem project, a major initiative funded by the European Union’s Horizon 2020 programme and the Bio-Based Industries Joint Undertaking (BBI JU, predecessor of CBE JU), officially came to an end on April 30, 2025. Over the last five years, the project has delivered on its promise to demonstrate an innovative, sustainable and scalable biorefinery model for converting biomass residues into high-value bio-based building blocks. Led by Afyren, the consortium has succeeded in creating a firstof-its-kind industrial plant that transforms sugar industry byproducts and organic waste into carboxylic acids and esters, providing greener alternatives to fossil-based products in a wide array of sectors. The partners and CBE JU officials met on June 25 in Metz and Carling Saint-Avold (France) to reflect on this successful journey and visit the plant.
Five years of technical and industrial achievements
Over the project’s 60-month duration (May 2020 – April 2025), After-Biochem mobilized 12 partners and a total budget of €33 million, including €20 million EU funding. The primary ambition to build and operate a flagship biorefinery capable of producing 16,000 tons per year of bio-based acids was achieved and led to the creation of close to 80 industrial jobs in Carling Saint Avold, France, to operate
the biorefinery (estimation of 250 indirect jobs contribution).
In the life of the project coordinated by Afyren, the After-Biochem partners proved their dedication to this innovative development. These combined efforts helped Afyren’s team to build the biorefinery (with the support of engineering group Technip), reach continuous production in June 2025 and demonstrate command of all key stages of the Afynerie® process, an anaerobic biomimetic fermentation-based process. Nicoló Giacomuzzi-Moore, CBE JU Executive Director commented: “The successful completion of the After-Biochem project marks a significant milestone for Europe’s bioeconomy. Led by the innovative company Afyren, this project puts sustainability and circularity at the heart of industrial transformation, demonstrating how cutting-edge bio-based solutions can make our industries greener and more resilient.”
Valorisation of non-food biomass residues
After-Biochem led to deeper industrial collaboration and knowledge on the valorization of biomass residues as feedstocks for chemistry. The project allowed optimized fermentation of sugar beet byproducts from Südzucker AG and a long-term contract has been established between the 2 companies to ensure a regional sourcing of sustainable
renewable raw materials for the plant Afyren Neoxy. The partnership allowed also the exploration of alternative feedstocks such as biowaste from Suez, for the bio-based acids production.
By achieving plant continuous production, Afyren will be able to provide the food, feed, flavors & fragrances, lubricants, life sciences and materials markets’ actors with sustainable alternatives to traditional ingredients. During After-Biochem, Afyren agreed supply contracts representing total cumulative revenue over €165 million to be recognized in upcoming years. The market success was also driven by several industrial leaders in the project, especially: Celanese, Kemin, Fiabila, and Firmenich. The valuable expertise of the partners on key markets defined the best practices for the collection of relevant feedback data on the biobased acids’ quality and efficiency in the industrial production process.
Another important focus was the valorization of byproducts to achieve a zero-waste process target. This was done by leveraging Terrial’s expertise. Several valorization routes were investigated, including composting and direct field application, ensuring zero-waste strategies, and thus reinforcing the project’s commitment to circular bioeconomy models. On the sustainability front, Sphera led an in-depth Life Cycle Assessment (LCA), Life Cycle Costing (LCC), Material Circularity Indicator (MCI) evaluation and a Social Life Cycle 2 Assessment (s-LCA). The analysis confirmed the biorefinery model developed by After-Biochem contributes significantly to reducing environmental impact, improving resource circularity, and supporting regional socio-economic development.







Merck chose IMA Life to solve an urgent need at their facilities in New Jersey. The primary objective was to obtain a flexible, multi-format Readyto-Use line that could handle highly potent products up to OEB5, while also accommodating live virus formulations.
Building relationships with customers who are as focused you are on innovation for a better world is a perfect starting point and premise for a successful project.
Merck & Co. Inc., a global health care company working to deliver innovative health solutions for today and the future, chose IMA Life to solve an urgent need at their facilities in Rahway, New Jersey.
A Global Engineering Services representative at Merck and Stefano Specchia, IMA Life Product Manager explain
the details of the project and gain insight into the mutual benefits.
The requirement
According to the customer, the primary objective was to source a flexible, multi-format RTU (Ready-to-Use) line that could handle highly potent products up to OEB5, while also accommodating live virus formulations. This required a robust and adaptable system that could manage a range of products, from serum-based to freezedried formulations, without compromising safety or process integrity. The
equipment needed to ensure compliance with stringent containment requirements, given the risk level of the substances.
The challenge
Given the equipment’s role as a replacement in an urgent situation, Merck narrowed its choice to those suppliers that were not only able to provide adequate support to address the specific needs of handling both potent compounds and live virus formulations, but also in a position to adhere to a strict delivery schedule.

The solution
A solution demanding rapid deployment was needed in order to avoid production delays and uphold commitments to stakeholders. Moreover, there were a number of critical requirements that only IMA Life was able to address satisfactorily.
Specchia underlines the key reasons why Merck opted for the fill-finish line constructed around Injecta: “First and foremost, our experience in handling complex, high-potency products and live virus formulations reassured the customer regarding the adaptability of our technologies and our ability to ensure safe processing without sacrificing operational efficiency. Furthermore: our solution met the technical specifications; we aligned well with the challenging timeline; we provided high-level digital training for Merck’s operators.”
In particular, training aimed at enhancing operational efficiency and ensuring consistent management of the line using standard working parameters. Seen as a crucial requirement, IMA Life was successful in fulfilling this need. According to the customer, there were “no doubts about their commitment to support and optimize our processes.”
The benefits
Advanced robotics, which is a core principle in terms of Injecta and its design concept, facilitated effective cleaning and containment when dealing with potent compounds. This feature is critical for compliance and safety in handling high OEB-level products. The design also supports greater precision, which is essential for minimizing contamination risks and im-


proving overall production reliability. The line is also easy to use. Recipe programming is intuitive and enhanced monitoring capabilities also contribute to potentially fewer rejects.
The ultimate value
Faced with a tight timeframe, a building that was not designed to accept the line initially, and a challenging path taking us from the first design phase of the processing line right up to commissioning, training and onsite support, IMA demonstrated “the true value of working with a trusted and committed partner in the field.”
At all times throughout the project – from the design phase all the way through to qualification and support –one of the key factors ensuring success had to be the partnership between the companies and especially the people working in each team.
In conclusion
Moving ahead, it is clear that IMA’s
commitment will not diminish thereby enabling the equipment to function as an integral part of the production environment across its entire life cycle.
IMA Life has supplied a fully integrated, isolated line that spans the entire process, from RTU container handling through freeze-drying and downstream operations, including external washing and tray loading. This comprehensive approach ensures seamless compatibility and operational efficiency across all stages of production, meeting the highest standards for containment, precision, and reliability.
Injecta is the first of a new generation of material handling technologies, setting new standards in the industry. The dedication of the IMA team, their depth of knowledge, and the support resources they provide are instrumental in ensuring timely and effective project outcomes. While certain areas of task execution and design may benefit from minor adjustments, this partnership has underscored IMA’s adaptability and readiness to push technological boundaries to meet evolving industry needs.
CSV Containment develops gravity-based reactor loading systems that optimize space, enhance safety, and streamline operations across multiple floors – all without requiring major plant modifications.
There are situations where, for various reasons, reactor loading must be performed using alternative methods. CSV Containment is able to evaluate the most suitable solution for your specific needs and implement it – as in the case of these configurations, all coming straight from above – quite literally this time. Working from the upper floor is sometimes the ideal solution. What might initially seem like a more complex setup can actually be driven by considerations such as space optimization, ease of operation, ergonomics, or other practical factors. Reactors are not always located in easily accessible or spacious environments. Barrel handling and product transfer might be more conveniently performed elsewhere, but the key challenge remains: how do you connect a glove box to a reactor if they are located on different levels?

Pumping or dropping – That is the question
Lifting the material up to the reactor requires a system capable of conveying powders – typically via pneumatic transfer – in a fast and safe manner. Between the charging station and the reactor, a pump could be integrated, but this is not always feasible. Moreover, pumps require more maintenance, increased safety checks, and additional energy consumption. Taking advantage of gravity for material transfer is undoubtedly simpler and faster, yet even this approach must account for safety measures and overall plant layout.
CSV Containment’s experienced engineers study and assess the entire process, managing the custom connection setup, glove box design, and –upon request – the integration of actuated valves to control the material flow.
Consent is always required
It’s not just about customer approval – the control systems must give their consent too. Reactor loading projects are fully managed – from the upstream isolator to the reactor’s connected piping.
In cases where pneumatic valves are used and actuated based on signals from the distributed control system (DCS), the technicians handle all related hardware and software integration.
CSV Containment’s programmers are experienced in interfacing with major DCS platforms on the market, including Siemens, Rockwell, Emerson, and ABB, among others.

Drop tubes and process separation
No need for vacuum or pressure – just free fall and valves designed to intercept and release material at the right moment. This makes it possible to create true “gravity chutes” between floors, allowing the drum loading area to remain completely separate from the reactor room. If at the upper level, drums are handled with ease using one of our charging stations equipped with integrated lifters, meanwhile, at the lower level, the product reaches the reactor safely and efficiently. The workflow remains continuous and streamlined – ideal for high-throughput environments particularly for facilities with substantial production capacity.
As each system is tailor-made, it fits seamlessly into the existing plant layout, avoiding the need for costly structural modifications. Additionally, it ensures clear process separation and improved cleanliness throughout the production environment.
CSV Containment provides tailor-made solutions for pharmaceutical and fine chemical sectors in terms of containment. For more info: containment@ csv-ls.com.
Source: www.csvcontainmentnews.com

The Romaco Innojet system enables Klocke Pharma-Service to produce granulates with a more homogeneous particle size distribution and hence better flowability, leading to higher tableting speeds.
by Josef Brändlin*
When it comes to producing and coating granulates, contract manufacturer Klocke Pharma-Service GmbH puts its trust in fluid bed technology from Romaco
Innojet. With its wide range of applications, short processing times, linear scalability, sparing use of raw materials and reliable, energy-efficient production processes, the VENTILUS® technology is tailor-made for the requirements of a contract manufacturing organization.
The Klocke Group is one of Europe’s leading contract manufacturing and packaging suppliers. Klocke Pharma-Service GmbH, at home in Appenweier in south-west Germany, processes a variety of raw materials into powder granulates and pellets, mainly for compression into tablets. The con-
tract manufacturer first started using Ventilus fluid bed processors from Innojet, a Romaco Group company, in 2014 and has continuously enlarged its stock of these technologies ever since. Klocke presently has six Innojet-built fluid bed processors at its disposal for carrying out wet granulation processes with aqueous and solvent-based binder media as well as for drying and pellet coating. In addition to a Ventilus pilot plant for batch sizes up to 50 liters, three production plants for up to 400 liters and two for up to 800 liters are in use today. The systems are designed to be compatible as regards product filters and spare parts, and upscaling from a smaller processing machine to a larger one is a simple matter.
“The Ventilus fluid bed processors from Romaco Innojet helped us achieve a technological leap forward”, reports Alexander Pergande, Managing Director Operations at Klocke Pharma-Service. “The uniform flow conditions in the machines and the precise bottom spray technology mean we can produce granulates with a more homogeneous particle size distribution and hence better flowability, leading to higher tableting speeds. What’s more, our service portfolio has been expanded on the basis of this technology, and we’re now also in a position to coat pellets or film-coat micro-tablets, which we couldn’t do with top spray technology.”
Patented air flow bed technology
It is the air flow bed technology developed by Dr. h. c. Herbert Hüttlin, which is internationally patented and has received numerous awards in the past, that makes this possible. The air used for this process is introduced through a special ORBITER® booster plate consisting of overlapping circular plates. The innovative Orbiter flow technology results in a toroidal prod-

uct movement in the cylindrical product container that gently intermixes the batch. The speed of the particles and their path through the container are clearly defined and reproducible, enabling the spray liquid evaporation rate to be precisely calculated and the dosage adjusted accordingly.
Significant reduction in drying times and process air consumption
Drying is rapid and homogeneous because the flow of process air is heated. “The Ventilus technology has improved the drying time of all of the products we manufacture – depending on the product properties, up to 30% shorter processing times can be realized compared to conventional technologies”, Pergande explains. Furthermore, with certain products, Klocke has managed to halve its process air consumption per kilogram of product (m3/kg) without any reduction in output – a powerful lever when it comes to cutting energy costs.
The Innojet technology has also resulted in improved raw material usage. Sediment formation on the booster plate is virtually eliminated owing to the innovative process air distribution system of the Orbiter. The central ROTOJET® bottom spray nozzle, via which the spray liquid is applied, al-
lows precise adjustment of the spray angle, effectively preventing spray loss. The SEPAJET® filter system, featuring filter bags that are continuously cleaned by a blowing-air rotor system, likewise plays a decisive role with respect to raw material usage. It ensures that, in the case of granulation, the powdery substances are held back in the process area, whereas during coating processes abrasion and other fine particles are removed from the material to be treated. Hot, conditioned process air is used for filtering – avoiding

A patented booster plate with a central bottom spray nozzle reduces drying times and process air consumption

any need for expensive compressed air.
“As a specialized contract manufacturer, efficient raw material usage is very important to us”, says Pergande.
“Thanks to Romaco Innojet’s fluid bed processors, we can achieve the same output with 10-15% less material on average, meaning we save between 3% and 30% depending on the product.”
Granulation and pellet coating in one process
Homogeneous particle size distribution results in better flowability and high tableting speeds
Klocke currently manufactures around 40 different products in the form of classic powder granulates using Romaco Innojet technologies. There are also a number of products for which the pellets are built up by coating. A simple parameter setting on the HMI panel is all it takes for machine operators to individually adjust the spray pressure, the volume of the airflow and the material sprayed when switching between granulation and coat-

ing. No mechanical conversion work is necessary on the machine and it is no longer essential to replace the spray nozzle. Accordingly, the Ventilus does not have to be discharged at the end of the granulation step but can proceed directly to pellet coating. That not only adds up to a huge time saving for producers –also, the risk of cross contamination is reduced and employee health and safety improved whenever critical substances are involved, because the material is treated in a closed process.
Individual solutions
The fluid bed processors in use at Klocke were specifically adapted by Innojet to the contract manufacturer’s existing production infrastructure. Besides the standalone version, one 400 liter and one 800 liter Ventilus system can be coupled up to a compulsory mixer.
Innojet has come up with a multi-section transfer stainless steel pipe connection with a specially designed product conveying aid for combined lines comprised of a compulsory mixer and a fluid bed processor. For example, the process air from the Ventilus is utilized here for pre-drying
in the compulsory mixer. Depending on their customer’s requirements, Klocke can use these fluid bed processors and compulsory mixers either individually or in a tandem arrangement, giving the contract manufacturer considerable flexibility where production planning is concerned. The Ventilus manages product drying extremely efficiently when installed in tandem, with upstream granulation in the compulsory mixer.
Development partnership for a new Flexijet nozzle
Romaco Innojet and Klocke Pharma-Service GmbH have steadily intensified their collaboration in recent years in the framework of a development partnership. At its facility in Appenweier, Klocke recently became the first user to go live with Innojet’s new FLEXIJET® nozzle. It is more robustly designed and easier to handle than its predecessor, the ROTOJET®, yet achieves the same spray quality and has already proven itself in practice at Klocke in all manner of applications.
“We greatly appreciate the open cooperation with Innojet, especially when the aim is to jointly develop strategies and solutions for meeting the daily challenges of contract manufacturing. In the opposite direction, we’re happy to share our experience – and assist in driving the ongoing advancement of Innojet technologies – with significant benefits for both companies in the long run”, asserts Alexander Pergande, Managing Director Operations at Klocke Pharma-Service. “The efficient, scalable and reliable technologies, backed up by competent and prompt service, make Innojet the ideal partner in our efforts to position ourselves successfully and permanently in the market as the contract manufacturer of choice.”


For Farmhispania, a leading company in the production of Active Pharmaceutical Ingredients (APIs), and its long-standing customer, Italvacuum has recently manufactured and installed an industrial-size vacuum tray dryer equipped with C.I.P. MULTISPRAY® patented fast washing system. This dryer will be used as an advanced drying solution in an industrial-scale pharmaceutical production process. The scope of supply, realized according to the customer’s specific needs and requirements, included: a design phase focused on customer requirements, with particular attention to customized solu-
tions for managing cooling water supply to the condensation unit; careful control of the gas flow rate during vacuum creation prevents wet product from being drawn out of the equipment; liquid discharge arranged at the back of the dryer to limit operations in the clean room. The scope of supply also included: steam heating and chilled water cooling unit; atmospheric expansion vessel; vacuum condensation unit with shell and tube condenser and condensate collection tank; VVC vacuum piston pump Saurus939; removable MULTISPRAY® diffuser for washing plates and the dryer’s internal chamber; con-
Following the first virtual presentation at Interphex, Syntegon is now introducing its new filling machine for ready-to-use (RTU) nested syringes to the market. The MLD Advanced meets the increasing requirements of pharmaceutical manufacturers for high output with 100 percent in-process control (IPC). “Especially with high-value medicines, it is essential that each drop is filled and weighed optimally,” explains Markus Burkert, Product Manager
at Syntegon. “That’s why we have combined the MLD platform, which was previously used primarily for cartridges and vials, with our technologies for syringe filling.”
The automatic bag and tub openers, well-known from many syringe lines, use no-touch transfer to ensure the aseptic transfer of the syringes into the filling area. The Pharma Handling Unit developed by Syntegon denests the syringes automatically without glass-toglass contact and places the con-


trol System with PLC and HMI for complete production recipe management; the SAT (site acceptance test) - completed in the presence of Italvacuum’s and customers’ technicians.
tainers into the pitch adjustment station. Here, the syringes are moved into the machine pitch and then placed in the clips of the machine transport. “This unique clip system is the first key feature we adopted for syringe applications from the cartridge line,” Markus Burkert explains. “The special circulating transport system ensures smooth transportation and is therefore ideal for RTU syringes, as well as vials and cartridges.”
The empty syringes are weighed using 100 percent IPC, before they are transferred to the filling station. The subsequent filling and stoppering process is based on the proven FXS series for syringes: the filling needles are mounted on the Pharma Handling Unit and allow for flexible redosing if required. Thanks to IPC, the filling weight is controlled precisely. “In addition to minimizing product loss, an important focus is on providing documented proof about the weighing of each container. This gives
manufacturers the certainty that all containers have been filled correctly,” explains Klaus Ullherr, Senior Product Manager at Syntegon. After stopper insertion via vacuum or vent tube, the containers are returned by the circulating transport system and gently placed in the nests by the Pharma Handling Unit. “This way, we can offer our customers a seamless process for their pre-sterilized syringes from a single source,” says Klaus Ullherr. Customers benefit from this innovative combination of proven technologies in several ways: in addition to achieving an output of up to 400 syringes per minute, they also receive safe and proven processes. “By using tried and tested technologies, the machine is available quickly, and the risk is significantly reduced,” Markus Burkert underlines. The first customer is already convinced: the first MLD Advanced will soon be ensuring gentle processing and filling of RTU syringes with 100 percent IPC at a European pharmaceutical manufacturer.


Specializing in explosion protection systems, StuvEx offers a wide range of solutions that cater specifically to the needs of the Italian market, known for its high industrial activity, including the chemical and pharmaceutical sectors, and strict safety regulations.

In industries ranging from oil and gas to pharmaceuticals, the risk of explosions is an ever-present concern. For businesses operating in sectors that handle flammable substances, protecting workers, equipment, and assets from the threat of explosions is paramount. This is where explosion safety solutions come into play, and one company standing out in this crucial field is StuvEx. Specializing in explosion protection systems, StuvEx offers a wide range of solutions that cater specifically to the needs of the Italian market, known for its high industrial activity and strict safety regulations.
The importance of explosion safety in Italy
Italy is home to a diverse range of industries, including automotive, chemicals, food processing, and mining.
Many of these sectors involve the use of flammable gases, liquids, and dusts, which, if not handled properly, can pose significant risks to human life and property.
Italy has stringent regulations to ensure the safety of industrial plants.
The ATEX (Atmosphères Explosibles) directive, which stands for Explosive Atmospheres, is one of the key safety standards in the country. It requires employers to take necessary precau-
tions to prevent explosions in areas where explosive atmospheres could potentially occur. The ATEX directive mandates the use of specific equipment that can operate in hazardous environments without triggering explosions, setting high standards for industrial safety.
To meet these regulations and prevent catastrophic accidents, businesses need reliable explosion safety solutions that offer both compliance and performance. StuvEx has been at the forefront of providing these solutions, offering a comprehensive range of products and services that ensure optimal safety for Italian industries.
Founded with the goal of providing cutting-edge explosion safety solutions, StuvEx has built a reputation for excellence in the field. With years of experience, the company has gained a deep understanding of the complexities and challenges that industrial facilities face in ensuring safety in potentially explosive environments. StuvEx is committed to offering innovative and effective solutions to its clients, and the Italian market is no exception.
StuvEx offers a complete range of services, from consultation and risk assessment to equipment supply and maintenance, ensuring that its clients receive end-to-end support. The company specializes in providing explosion protection solutions for both gas and dust explosive atmospheres, helping clients mitigate the risk of fires, explosions, and other hazards that can arise in industries such as chemical processing, food production, pharmaceutical manufacturing, and more.
StuvEx offers a variety of products designed to safeguard industries against the risk of explosions. These products are specifically engineered to meet both the requirements of the ATEX directive and other international safety standards. The primary products and services provided by StuvEx include: Explosion-proof electrical equipmentStuvEx manufactures and supplies explosion-proof electrical equipment that is certified to operate safely in hazardous areas. This includes electrical panels, lighting systems, motors, and switches that are built to withstand the pressures and conditions of explosive environments. StuvEx ensures that each product is tested for compliance with ATEX standards, guaranteeing maximum safety for Italian industries.
Flame arresters and explosion vents - Flame arresters are critical components in preventing the propagation of flames within pipes and vents in industries where combustible gases or vapors are present. StuvEx provides high-quality flame arresters and explosion vents that can handle both low and high-pressure situations, preventing the risk of explosion from spreading throughout a system. These products are particularly useful in the chemical and petrochemical sectors, common industries in Italy, where flammable gases are used.
Explosion isolation systems - Explosion isolation is an essential part of a comprehensive explosion safety strategy. StuvEx offers explosion isolation systems that are designed to stop the spread of explosions between sections of industrial equipment. By using innovative isolation valves and other advanced technology, these systems prevent the destructive effects of an explosion from affecting other parts of the facility. This is especially important in large facilities where interconnected systems are common.
Dust Explosion Protection - Dust explosions are a serious concern in many industries, particularly in food processing, metalworking, and wood processing. StuvEx provides dust explosion protection equipment that meets the specific needs of each industry, ensuring that dust collection systems and processing equipment are safeguarded against potential ignition sources. The company’s range of explosion protection solutions includes explosion suppression systems, explosion vents, and dust filtration systems that help prevent the ignition of dust clouds. Consultation and Risk AssessmentBeyond providing equipment, StuvEx excels in offering expert consultation and risk assessment services

to its clients. Understand ing the spe cific risks as sociated with each business is es sential to determin ing the right explosion protection strategies. StuvEx’s team of experts works closely with Italian businesses to assess potential risks, analyze hazards, and design customized solutions that mitigate those risks effectively.
Training and Maintenance ServicesEnsuring the ongoing safety of an industrial facility requires continuous monitoring, maintenance, and training. StuvEx offers training programs for employees to ensure they understand the importance of explosion safety and how to use safety equipment effectively.


A holistic approach to mitigating risks posed by solid particle hazards, which incorporates an understanding of guidelines, key contamination risks, and the latest garment solutions, is crucial for HSQE managers to safeguard their workers.
Solid particles in industrial and manufacturing environments pose significant hazards to employees and present complex challenges for health and safety professionals. In this Q&A, we speak to Steve Marnach, EMEA Training Manager & Specialist Critical Environments at DuPont Personal Protection about the health risks associated with dust ex-
posure, the challenges HSE managers face in protecting workers, and best practices for selecting appropriate personal protective equipment (PPE).
Steve Marnach, solid particles are commonly referred to as “dust”. Why is this material harmful to humans?
“Exposure to various dust types, in-
cluding Polychlorinated biphenyls (PCB) dust, mineral and chemical particles, and powder coatings, can lead to health issues, including skin irritation, respiratory diseases, cancers, and even death. From an occupational health perspective, dust is categorized based on its physical and chemical properties that determine its potential health impact. There are three categories: inhala-

DuPont has published an E-Guide to assist HSE managers in understanding, assessing, and mitigating solid particle risks, and to provide guidance on selecting appropriate protective garments for workers. The E-Guide can be downloaded here:
https://www.dupont.co.uk/personal-protection/dust-particle-protection.html?src=EMEA-EN_PP-PPTyvek-ChemicalIndustrial_PR_Internal_SolidParticles_032025#eguide
equipment and expertise. Variability in exposure over time and across different tasks adds to the challenge for HSE managers.”
How many workers are affected by workplace respiratory diseases?
ble dust, thoracic dust, and respirable dust. Inhalable dust refers to larger-sized particles, most of which will be filtered out in the nose and throat.
Thoracic dust refers to the smaller-sized dust particles that can reach the lungs. Finally, respirable dust is small enough to be inhaled deeply, penetrating the gas-exchange region of the lungs.”
What are the most common sources of harmful dusts?
“Common sources of harmful dusts include industrial processes like manufacturing, construction, mining, and quarrying. Activities like grinding, cutting, drilling, and sanding can generate dust and other harmful particles. Additionally, agriculture, woodworking, vehicle exhaust, and household dust can contribute to dust exposure.”
Are dust hazards easy to identify?
“It depends. While some dust is visible, it can also be microscopic. Accurately measuring airborne particle concentrations requires specialized
“Nearly 3 million people globally die each year due to work-related causes, according to the International Labour Organization (ILO)”. Of these, a large portion are attributed to workplace respiratory diseases, which, along with circulatory diseases and malignant neoplasms, are counted among the top three causes of work-related deaths. Echoing this sentiment, the World Health Organization reports that workplace exposure to air pollution including particulate matter, gases, and fumes were found responsible for 450,000 deaths.
The EU-OSHA Workers’ Exposure Survey (WES) on cancer risk factors in Europe is working to address the lack of data surrounding this threat. Initial findings suggest that there is an increased risk for workers in micro or small-sized workplaces compared to medium-sized or large
workplaces and for those working over 50 hours a week (https://osha.europa.eu/en/publications/occupational-cancer-risk-factors-europe-first-findings-workers-exposure-survey).”
What role does protective clothing play in preventing dust exposure?
“It’s of paramount importance in preventing particles such as asbestos and polychlorinated biphenyls (PCBs) from entering the human body, particularly through skin contact. However, HSE managers need to make the right PPE choices, or workers may become more exposed to solid particles. Reusable workwear, for example, can inadvertently spread hazardous solid particles, exacerbating exposure risks during removal”.
What special properties should HSE managers look for when selecting protective clothing for protection against dust hazards?
“Standard protective overalls are ineffective against solid particle hazards as they are made from woven materials that allow dust particles to pass easily through the holes. Gar-
“Accurately measuring airborne particle concentrations requires specialized equipment and expertise. Variability in exposure over time and across different tasks adds to the challenge for HSE managers”
DuPont is a global innovation leader with technology-based materials and solutions that help transform industries and everyday life. The company employees apply diverse science and expertise to help customers advance their best ideas and deliver essential innovations in key markets including electronics, transportation, construction, water, healthcare and worker safety.

ments made from special, non-woven materials with advanced barrier properties are necessary to provide superior protection against even the smallest airborne particles. For example, DuPont™ Tyvek® material is a non-woven fabric of spun polyethylene fibers. It offers superior protection against airborne particles as small as 1-2 μm.
Garments should also have good tear and abrasion resistance and a smooth surface to prevent particles from adhering to the material. Antistatic treatments can help in this regard. Look for garments that have taped seams and protective flaps over the zippers and fasteners, which
offer added protection from particle penetration. Check that there is a good elasticated seal at the wrists and ankles and that the garment is fully compatible with other PPE such as masks, goggles, and gloves.”
Are there any regulations governing protective clothing choices?
“Yes. Regulation (EU) 2016/425 mandates the use of Category III Type 5 protective clothing for protection against solid airborne particles.
These garments, such as chemical protective coveralls, must meet EN ISO 13982-1 standards and pass a penetration cabin test to ensure they

“Taking a holistic approach by regularly reinforcing safety messages and providing comprehensive training, with a focus on correct donning and doffing procedures, can significantly reduce the risk of exposure to hazardous substances”
effectively prevent dust penetration. The test involves exposing the garment to a controlled dust cloud and measuring the amount of dust that penetrates the material. To pass the test, the garment must achieve specific inward leakage limits.
HSE managers must identify complex hazards, accurately quantify exposure levels, and familiarize themselves with the specific barrier properties required.
It’s important to stress that while Type 5 protective clothing offers a minimum level of protection against solid particles, it’s not completely impervious. To achieve the best protection for their application, HSE managers should consider the specific penetration rates of garments. This information should be stated on the manufacturer’s product sheet.”
Finally, what additional steps can HSE managers take to further safeguard “workers from solid particle hazards?
“Educating workers about the risks of invisible hazards can be challenging, especially for those working with seemingly benign substances, such as flour dust. Ensuring workers understand the risks and follow safety protocols is equally as important as selecting the right level of protective garment.
Taking a holistic approach by regularly reinforcing safety messages and providing comprehensive training, with a focus on correct donning and doffing procedures, can significantly reduce the risk of exposure to hazardous substances.
Collaborating with reputable PPE manufacturers like DuPont, which offer training resources, can help to further strengthen worker education, and promote best practices in personal protection.”
A preliminary assessment of environmental conditions is essential in contamination control. Aware of this, S4S offers an exclusive analysis and monitoring service in production areas.

When it comes to implementing effective solutions for contamination control, the preliminary evaluation of environmental conditions plays a crucial role. As an expert in the field, S4S fully understands the importance of this phase and offers an exclusive service of analysis and monitoring within various production environments.
S4S specializes in providing problem-solving solutions, operating across various sectors – from the pharmaceutical to the food industry – while always ensuring compliance with the latest regulations and cutting-edge technologies in air control and contamination management.
Optimizing airflows and ensuring compliance
The main goal of this preliminary ser-
vice is to ensure that airflows are optimized and that every corner of the client’s facilities is designed to guarantee not only operational efficiency but also full compliance with current air quality regulations.
In-depth analysis with advanced tools
S4S’s team of specialists uses stateof-the-art equipment to conduct a thorough analysis of air quality and airflow in production areas. This detailed assessment provides a clear and precise overview of the situation, highlighting even the slightest deviations or inconsistencies.
Tailored solutions for a personalized strategy
Thanks to the data collected during


this preliminary phase, S4S is able to precisely calibrate the proposed solutions, such as integrating laminar flows and other key tools for contamination control.
The result is a personalized strategy tailored to the specific needs of each production environment, ensuring flawless contamination control.
The preliminary service offered by S4S is not just an added value: it represents an essential step toward fully optimizing the response to contamination risks.
Relying on S4S’s extensive expertise in air quality monitoring and management allows any production space to be transformed into a safe and fully compliant environment.
Covestro has made circular economy a guiding principle –and is showing the way forward in the plastics industry by fully committing to it. A look at the latest developments from Leverkusen.
by Christine Böhringer
Polyurethanes are ubiquitous. For the past 90 years, these all-rounders of the plastics world have been bringing comfort, stability and weather-proofness to our lives. As liquid coatings, they impart hard-wearing surface finishes to cars and floors. In the form of adhesives, they hold shoes and books together. The synthetic polymers are also essential to the furniture industry, in the form of flexible foams used for upholstery and mattresses. They are in rigid foams too, the kind that thermally insulate refrigerators and millions of buildings, thus boosting energy effi-
ciency and making a significant contribution to climate protection.
In the midst of change
Yet polyurethanes have some catching up to do in terms of their own sustainability. Like almost all of the world’s 414-million-tonne annual plastics output, they are generally made from petroleum products – a pathway that generates CO2 emissions and drives climate change. And, at end of life, they wind up in landfills or incinerators. According to the OECD, only nine percent of the world’s plastic waste is recycled. But things are changing. “More and more chemicals companies are starting to rethink polymers. The industry is in
the midst of a fundamental transformation process,” says Thomas Pellender, technical sales manager for the chemical industry at Endress+Hauser Germany. The pioneers here include Covestro, one of the world’s leading manufacturers of high-quality plastics and plastics intermediates. “The circular economy has been a guiding principle for us since 2019, and we are fully committed to it. We can’t achieve climate neutrality without circularity,” explains Dr Thorsten Dreier, chief technology officer at Covestro.
Covestro’s aim with its strategic program is to transition the production of plastics and their chemical constituents to environmentally friendly and


climate-neutral alternatives wherever possible. Hence, the company makes increasing use of bio-based raw materials and renewable energy in its production processes. Alongside this, it is developing innovative, energy-efficient technologies to optimize the mechanical and chemical recycling of end-oflife products and unavoidable waste. The idea is that products and processes should be circular by design. Thorsten Dreier: “In all areas, we are cooperating with actors from across the value chain and the science community and forging new partnerships to find solutions that are best for the circular economy.”
Building block of the future
Yet polyurethanes have some catching up to do in terms of their own sustainability. Like almost all of the world’s 414-million-tonne annual plastics output, they are generally made from petroleum products – a pathway that generates CO2 emissions and drives climate change. And, at end of life, they wind up in landfills or incinerators. According to the OECD, only nine percent of the world’s plastic waste is recycled. But things are changing. “More and more chemicals companies are starting to rethink polymers. The industry is in the midst of a fundamental transformation process,” says Thomas Pellender, technical sales manager for the chemical industry at Endress+Hauser Germa-
ny. The pioneers here include Covestro, one of the world’s leading manufacturers of high-quality plastics and plastics intermediates. “The circular economy has been a guiding principle for us since 2019, and we are fully committed to it. We can’t achieve climate neutrality without circularity,” explains Dr Thorsten Dreier, chief technology officer at Covestro. Covestro’s aim with its strategic program is to transition the production of plastics and their chemical constituents to environmentally friendly and climate-neutral alternatives wherever possible. Hence, the company makes increasing use of bio-based raw materials and renewable energy in its pro-
duction processes. Alongside this, it is developing innovative, energy-efficient technologies to optimize the mechanical and chemical recycling of end-oflife products and unavoidable waste. The idea is that products and processes should be circular by design. Thorsten Dreier: “In all areas, we are cooperating with actors from across the value chain and the science community and forging new partnerships to find solutions that are best for the circular economy.”
That the pilot plant’s process monitoring systems include Endress+Hauser measurement technology almost goes without saying. “Endress+Hauser is one of the suppliers with whom Covestro has a long-standing partnership,” says Sebastian Mahler, head of process control technology at Covestro. Indeed, it is a partnership that goes back decades. Covestro was created from the spin-off of Bayer AG’s plastics division in 2015 and previously did business as Bayer MaterialScience. A supplier agreement with Bayer concluded back in 2003 means that Covestro uses Endress+Hauser instruments as standard in its plants all over the world. “Our relationship with Covestro is very close

Covestro develops new technologies at its headquarters in Leverkusen, Germany
At a pilot facility, the company pioneers the production of bio-based aniline

and reliable at all levels, from service technicians to senior leadership. We get onboarded in their projects at an early stage. This means we are in dialog with their technical people and can recommend the best sensors for their needs and advise them on systems design,” explains Endress+Hauser technical sales manager Thomas Pellender. Covestro’s Sebastian Mahler agrees: “On the technical side, this is a partnership between equals. Endress+Hauser, like few other companies we deal with, is

willing to dive deep into the special technical requirements of our processes to see if they can be realized. We and our counterparts are mutually supportive and can also provide input to further developments in both organizations.” At Covestro, a prime function of measurement technology is to keep plant and equipment operating reliably and efficiently, which in turn reduces consumption of energy and raw materials and minimizes waste. “Measurement technology is fundamental to the development of new processes,” Mahler says. “It provides the basis for deep understanding of processes and for determining and calculating scale-up factors.” High-precision measurements enable Covestro to test, understand and optimize new technologies so that it can progressively scale them up to the point where they can be used for fullfledged industrial production.
Several instances of such upscaling are currently under way on the Covestro factory campus. As an example, a pilot plant for bio-based hexamethylene diamine (HDMA), a precursor for liquid coatings and adhesives, has been operating since 2022. Covestro developed the process technology for this in partnership with US biotech company Genomatica. “Whatever the project, partnerships are important for us because synergizing specialist expertise brings us closer to our goals,” says Thomas Vössing. The same is true for the 20-plus projects where Covestro is researching novel recycling methods. “Alongside research into raw materials from new, bio-based sources, we are vigorously driving the development of these innovative recycling technologies. Our vision is to become fully circular and climate neutral, and we are pursuing all avenues for innovation that can bring us closer to this goal,” explains
Thorsten Dreier, Covestro’s chief technology officer. “Recycling has the potential to take us a long way towards closing the loop and transforming waste into raw materials that we can use in production.”
In another pilot plant, Covestro and its partners have achieved an initial breakthrough in chemical recycling. The plant recycles polyurethane flexible foams from used mattresses a worthwhile endeavor, considering that each one contains on average 15–20 kilograms of the material. The uniqueness compared with other chemical methods is that the Covestro chemical recycling technology, Evocycle CQ, is able to recover both main constituents of polyurethane – polyol and the precursor to diisocyanate – at high levels of quality and purity. In contrast, Covestro’s enzymatic recycling technology is still in early-stage development. This biotechnological approach uses enzymes to decompose plastics into monomers which can then be used for producing new plastics of equivalent quality to virgin material. The advantage of enzymatic recycling is that it takes place at very mild temperatures and produces few to no by-products. As such, it brings the chemicals industry a whole lot closer to the closed-loop systems of nature, where there is no waste and everything is recycled.
While these are important milestones, Covestro still has a long way to go before it achieves full circularity across its entire production landscape for plastics and their constituents. But for CTO Thorsten Dreier, one of the people tasked with championing the circular economy strategy at Covestro, these and other key milestones are cause for confidence: “We are making new advances in all areas almost on a daily basis. That having been said, we’re still a long way from reaching our goal.”
Source: www.endress.com
The state-of-the-art ANS/ANM58 Profinet from SICK Sensor Intelligence marks a new generation of absolute encoders specifically designed for higher machine and system productivity. Available in both single-turn and multiturn variants, the compact ANS/ ANM58 comes with the Profinet global, cross-industry ethernet fieldbus standard for industrial automation. It delivers rapid, bi-directional communication with PLCs for shorter cycle times, high precision movement control and fast integration. The ANS/ANM58 Profinet provides increased productivity across a diverse range of factory and logistics automation applications. In automated machines and systems, encoders provide the basis for efficient and controlled monitoring of the move-
ment of drives and axes via rotary sensors measuring position, speed and displacement. From the launch of the first encoder in 1960, SICK has poured 65 years of expertise in encoder technology into the design of the ANS/ANM58, including an improved optical measurement system for high precision movement control. The new range meets growing customer demand for precise and clock-synchronous motion control, condition monitoring of machines and systems, short cycle times, space-saving design and easy installation. With the ANS/ANM58 series, users can configure their ideal encoder, choosing from single-turn or multiturn measurement with resolutions of 18 bit (262,144 steps/turn) or 34 bit (262,144 steps/ turn x 65,536 turns) to suit the applica-

tion. The new ANS/ANM58 absolute encoders offer a flexible, space-saving design ideal for tight and demanding installation scenarios, with best-in-class compactness starting from as little as 39 mm long. It has a wide variety of mounting options, including flat or narrow housing designs, as well as axial or radial plug variants. The ANS/ANM58 comes in solid shaft, blind hollow shaft or through hollow shaft options for transmitting rotational movement information, and a variety of flanges for flexible mounting. It can be installed directly onto mechanics or mounted with a wire draw mechanism or rotary measuring wheel for linear motion monitoring.
Rockwell Automation, Inc. announced that Swiss company Sintetica SA has adopted the FactoryTalk® PharmaSuite® manufacturing execution system (MES) from Rockwell Automation as a driving force behind its expansive digital transformation.
Established in 1921, Sintetica produces multiple innovative therapies, including drugs for anesthesia, pain management, intensive care, and neuromodulation. As part of a wider digitalization initiative, it will use the PharmaSuite MES at a production facility in Switzerland to improve quality, monitoring, in-
sights, and external interactions, while also leveraging quicker batch reviews to shorten time to market.
“Pharmaceutical companies are under operational pressure, not just from consumers, but also industry and legislative bodies,” said Roger Gaemperle, EMEA head of industry strategy and marketing, life sciences, Rockwell Automation. “The creation of a digital foundation at the beginning of any production operation establishes faster and easier access to essential insights along the entire length of the value chain. It is in this role that our PharmaSuite MES
is driving value for pharmaceutical customers.”
Rockwell Automation consultants worked closely with Sintetica during the design and implementation phases, where the software’s agility allowed it to be modified – even late in the program –so it could more closely match Sintetica’s precise needs as they further evolved.
Since its pilot deployment on two lines, operator feedback has proved immensely positive, with the data-driven insights and actions empowering people and reducing the time spent monitoring, recording, and disseminating
essential batch information and operational machine logs. “Our digital transformation is a comprehensive journey of self-improvement,” said Pierluigi De Rosa, digital affairs – application manager, Sintetica. “It is driven by a desire to become more efficient across our production operations and to enhance our quality assurance and legislation programs. Although it is not yet being used along all product lines, it is being used at the preparation stage for the majority, delivering a stronger and more accurate starting point for all projects.”

by Adam Cross
Industry Director
Pharma companies are under increasing pressure to boost efficiency, enhance sustainability and strengthen security. Cloud-based solutions like HxGN EAM are playing a key role in actively addressing these challenges.
The pharmaceutical industry is one of the most heavily regulated sectors in the world, where precision, compliance and innovation are not optional – they’re essential to success. Pharma companies are under increasing pressure to boost ef-
ficiency, enhance sustainability and strengthen security. Cloud-based solutions like HxGN EAM (Enterprise Asset Management) are playing a key role in actively addressing these challenges.
But what does that actually look like day to day? How can a cloud-based
asset management system make a real difference to your operations?
1. Reducing risks while enhancing security
Cyber threats are increasing, and pharmaceutical companies face strict, ever-changing regulations. Strong data

security is a must, not just to meet Good Manufacturing Practices (GMP) rules but also to keep operations running and protect trust with patients and partners.
HxGN EAM’s cloud-based platform offers:
- State-of-the-art security features: the cloud automatically updates your systems, helping protect you against new cybersecurity threats and vulnerabilities.
- Ensure compliance with global standards: HxGN EAM is designed, developed, tested and released to support GMP compliance.
It ensures companies maintain rigorous standards while benefiting from a secure, validated environment.
By transitioning to the cloud, pharma companies can shift the burden of managing security updates to trusted experts, allowing them to focus on their core mission: delivering life-saving therapies to patients worldwide.
2. Stay ahead with the latest innovations
Innovation is at the core of the pharmaceutical industry.
To stay competitive, companies need access to the latest tools that improve how they work and deliver value across the business.
HxGN EAM’s cloud–based platform offers:
- Continuous updates and new features: cloud-based platforms regularly update and enhance the features, helping you stay ahead without waiting for lengthy and costly upgrades and validation cycles.
- Testing and validation capabilities: Pharma companies can validate updates using a dedicated test environment and a risk-based approach, ensuring compliance with

GMP standards without disrupting operations. This approach lets organizations add new capabilities and innovate at their own pace, without disrupting key processes or compromising validation requirements.
3. Boost efficiency and operational control
Running on-premises systems is time-consuming and often pulls teams away from more strategic
work. Moving to the cloud helps simplify daily operations and frees up resources for what really matters.
- Reduced IT burden: With cloudbased systems, there’s no need to maintain servers or handle updates yourself. That means lower costs and fewer demands on your IT team. freeing up valuable resources.
- Scalability and flexibility: as your business grows, the cloud can

HxGN EAM is designed, developed, tested and released to support GMP compliance.
It ensures companies maintain rigorous standards while benefiting from a secure, validated environment

in, check asset status and collaborate in real-time, all they need is an internet connection.
4. Maintain control while ensuring GMP compliance
The most common concern about cloud adoption is whether it compromises control or regulatory requirements.
HxGN EAM is purpose-built to eliminate that worry.
- A dedicated test environment: safely test and validate updates before promoting them to production.
- Comprehensive audit trails and documentation: tools for documentation and audit trails provide com -


scale with you, ensuring that your asset management system evolves to meet your needs.
- Global accessibility: Whether onsite or remote, your team can log
plete transparency and audit readiness.
- Regulatory compliant features: HxGN EAM allows monitoring compliance through features like e-signatures or electronic record-keeping. These functionalities ensure that companies can confidently transition to the cloud without compromising quality, compliance or operational integrity.
5. Use data to make faster, more informed decisions
Cloud-based systems like HxGN EAM give pharma companies access to real-time data across sites, equipment and teams. That data helps
them make faster decisions, cut waste and identify areas for improvement.
With HxGN EAM, companies can:
- track asset performance and spot issues eaerly;
- plan maintenance based on actual use, not just fixed schedules;
- connect with other control systems to improve efficiency and simplify audits.
The result? Better uptime, stronger compliance, and progress toward sustainability, without extra complexity.
The pharmaceutical industry is changing rapidly and companies using digital technologies are set up for long-term success. Moving to the cloud with HxGN EAM is a smart, future-ready move that offers:
- reduced risk and enhanced security;
- a platform for continuous innovation;
- improved efficiency and operational control;
- built-in support for meeting regulatory standards.
The time to act is now
Pharmaceutical manufacturers are already shifting to the cloud, not as a trend, but because it solves real problems.
With HxGN EAM, companies gain better control over their operations, reduce compliance risks and keep up with regulatory demands without adding complexity.
If you’re looking for practical ways to improve how your business runs, now’s the time to make the move. For forward-looking pharmaceutical leaders, moving to the cloud offers a clear path to simplify compliance and improve operational control.
Emerson announced the release of the Rosemount™ 490A Optical Dissolved Oxygen Sensor, a digital Modbus-enabled measurement device designed to enhance operational flexibility, simplify installation and reduce maintenance costs across many industrial applications in the water/wastewater treatment, biopharmaceutical manufacturing, food and beverage processing, and steam power generation industries.
Most dissolved oxygen probes for industrial applications are made for installation in specific and relatively benign conditions. These sensors are often only capable of communicating
process values via analog signals to control systems, and they require frequent calibration to maintain accuracy and avoid sensor drift.
To address these and other issues, the Rosemount 490A provides reliable and accurate dissolved oxygen measurements in demanding environments, while simplifying integration into existing control systems with digital and universal Modbus RTU communication via an accompanying transmitter. In addition to producing accurate readings within just 90 seconds of transition from dry to wet conditions, this versatile sensor is capable of measuring process me-
dia in both liq uid and gas phas es, without requiring separate calibrations.

The Rosemount 490A employs Environmental Protection Agen cy-approved luminescence-quench ing technology, eliminating the need for electrolyte refills to significantly reduce maintenance requirements compared to traditional amperometric sensors. Its two-year sensing cap lifespan further minimizes downtime and associated costs, and it can be calibrated in free air.
Lauda dr. R. Wobser Gmbh & CO. KG, world market leader for precise temperatures, is expanding its digital portfolio and introducing the new version of its Command Professional app. With considerably expanded functions and continuous further development through updates via the leading app stores, the innovative application enables the comprehensive remote control and monitoring of constant temperature equipment on mobile end devices within the company network.
For several years already, the Lauda Command app has been a reliable and established tool for the basic remote control of constant temperature equipment. It offers users in research and industry comprehensive control over their temperature control processes. An intuitive interface allows users
to monitor temperatures in real time, adjust settings and receive alarm messages.
The Professional version elevates the digital control of temperature equipment to a new level.
“With the Command Professional app, we are forging new paths in the digital transformation of temperature control technology,” says Dr. Gunther Wobser, President & CEO of Lauda. “It combines flexibility with simple process control and a considerably expanded range of functions.”
In addition to all the functions of the free Command app, such as the direct input of temperature set points, simple adjustment of parameters and access to the basic settings, the Lauda Command Professional app offers numerous further options to make working with constant temperature equipment even
easier. A programmer enables the user to program, save and start a temperature-time program. Up to five different programs can be saved. Temperature curves can be displayed graphically and exported as image files. Furthermore, measured values and set points in the graphic temperature curve can be recorded and exported for further analysis or reporting. Data security is at the front and center of the app, which operates exclusively within the protected company network. All data is transferred in encrypted form – two-factor authentication and digital certificates (PKI) additionally ensure the necessary security. The app supports the relevant Machinery Directive for constant temperature equip -

ment and can be seamlessly integrated in existing laboratory infrastructure.
“The Lauda Command Professional app is more than a remote control system – it is an important step towards more connected and efficient laboratories and production facilities,” remarks Enrico Bossart, Head of Product Management. “The app allows us to support our customers in the digitalization of their processes, while preserving the Lauda precision and reliability they have come to expect.”
MANAGING DIRECTOR: Simone Ghioldi
EDITORIAL BOARD: Alessandro Bignami (a.bignami@interprogettied.com), Eva De Vecchis (e.devecchis@interprogettied.com)
COLLABORATORS: Christine Böhringer, Adam Cross
INTERPROGETTI EDITORI S.R.L. via Roggia Borromea, 16 - 22060 Carugo (CO)
Editorial, sales and subscription offices
Tel./fax +39 031 3665163 www.interprogettied.com
SALES DIRECTOR: Marika Poltresi
SALES: Simone Ghioldi (vendite@interprogettied.com)
ADMINISTRATION: amministrazione@interprogettied.com
SALES OFFICE: Raffaella Sepe (raffaella@interprogettied.com)
©Copyright Interprogetti Editori Srl
The columns and news are realised by the editorial team. All rights reserved – All reproduction, even partial, of published material without the publisher’s consent is strictly prohibited.
SUBSCRIPTION RATES:
Italy: ordinary mail delivery EUR 45.00, COD delivery EUR 48.00
International: ordinary mail delivery EUR 60.00, express delivery within Europe EUR 70.00
Express delivery to Africa, America, Asia: EUR 85.00
Express delivery to Oceania: EUR 100.00
Single copy: EUR 10.00
The VAT on subscription prices as well as on the price of single copies is paid by the publisher pursuant to article 74, sub-section 1, point C of the Italian DPR n. 633 of 26th Oct 1972 and subsequent amendments and additions. It is therefore not possible to issue invoices.
Registered at the Court of Milan on 7 May 2010 no. 259
Managing Director: Simone Ghioldi
Printed on August 28th, 2025 at Litogi, Milano
Information to be given to the data subject - art. 13, legislative decree 30th June 2003, no. 196. Personal data are processed, with or without the help of electronic means, by Interprogetti Editori S.r.l. - vis Maggiolino, 34 F - 23849 Rogeno (LC), Italy, to send you the magazine requested and for the operations connected. The processing of data will be carried out by the persons who have been committed by the controller the task of performing the processing operations connected with recording, modification, processing of personal data and printing, fulfilment and delivery of magazines, commercial and fiscal issues, accounting and call center activity. With reference to art. 7, Italian legislative decree 196/2003, you have the right to access to your data, modify, update or cancel data or to object to their processing for direct marketing purposes, by writing to the controller, and ask for the list of data processors.
Publisher’s information to public – art. 13, legislative decree 30th June 2003, no. 196. With reference to Italian Personal Data Protection Code and art. 2, point 2 of Code of Conduct for the processing of personal data in the exercise of journalistic activities, Interprogetti Editori S.r.l. informs that the place where personal data, images and photos are kept is Rogeno (Italy). Data can be used by journalists, free-lance journalists, persons in the role of trainee journalists and persons who carry out processing for the publication or occasional circulation of essays, articles and other intellectual works for the purpose of the exercise of their journalistic or similar activities. The processing of data will be carried out by the persons mentioned above and by persons in charge of printing and publishing activities. With reference to art. 7, Italian legislative decree 196/2003, you have the right of access to your data, modify, update or cancel data or to object to their, by writing to Interprogetti Srl, and ask for the list of data processors. It is understood that the provisions concerning professional secrecy in the journalistic profession shall be left unprejudiced as related to the source of the information if a data subject requests to be informed of the source of the personal data processed by journalists.










Our team offers customized, cutting-edge pharmaceutical synthesis solutions and the formulation of medical devices and food supplements all year round through ongoing commitment to ensuring prompt and accurate deliveries.
Our team offers customized, cutting-edge pharmaceutical synthesis solutions and the formulation of medical devices and food supplements all year round through ongoing commitment to ensuring prompt and accurate deliveries.
Expertise, quality and safety. Choose Qores, the ideal business partner for a successful future all together. qores.it
Expertise, quality and safety. Choose Qores, the ideal business partner for a successful future all together.